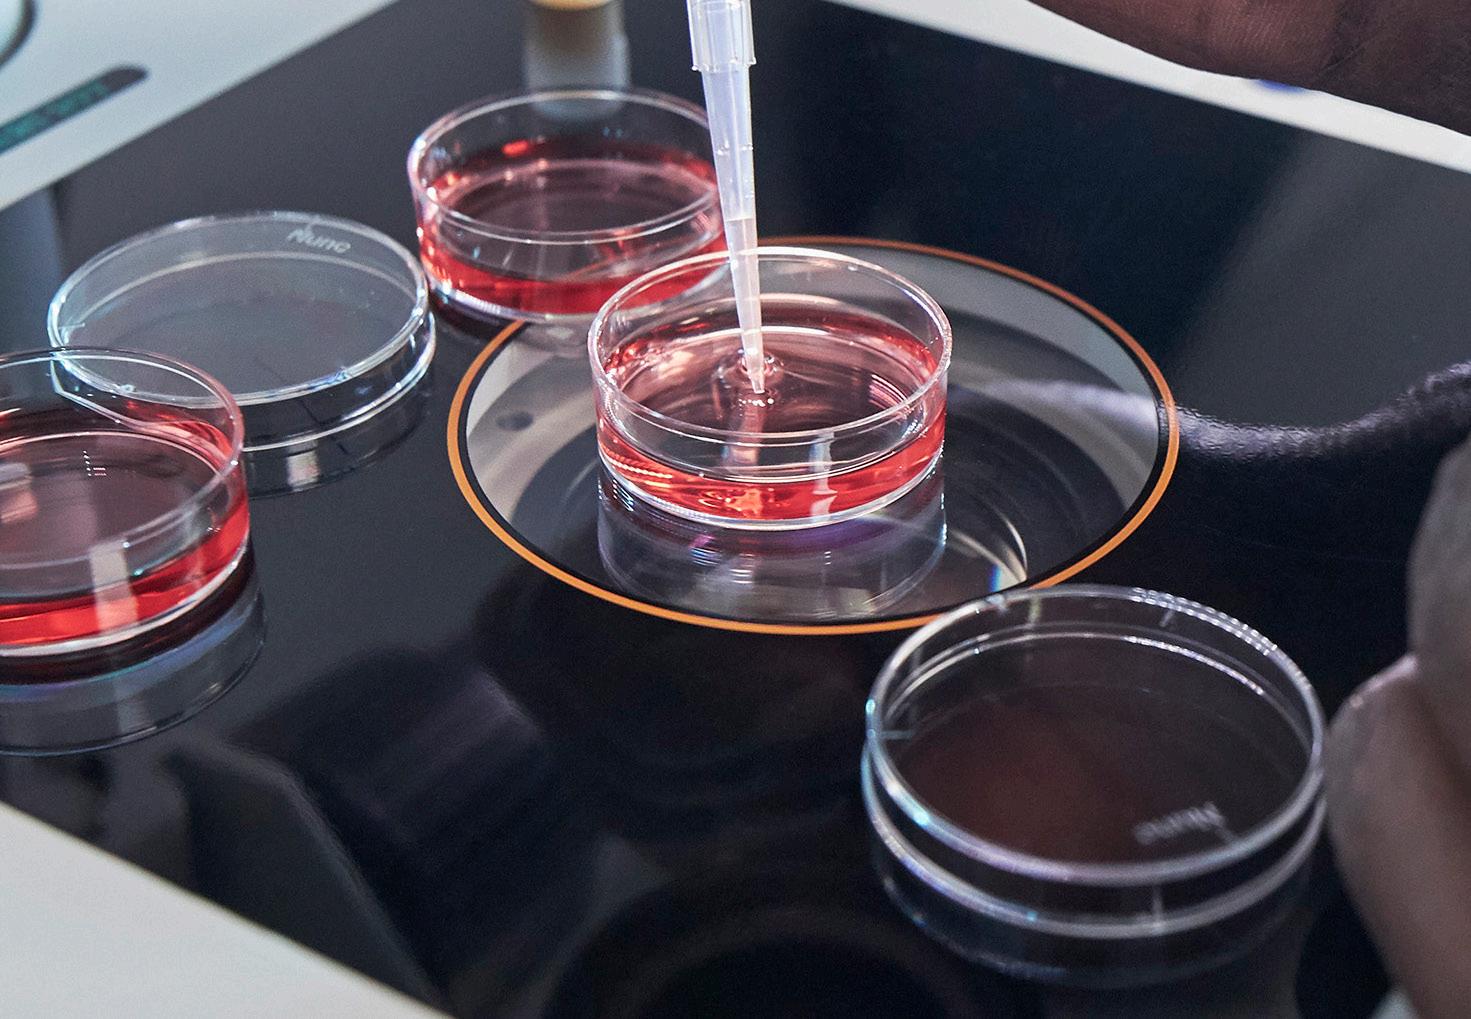

2023 BEEF MANAGEMENT HANDBOOK
2023 BEEF MANAGEMENT HANDBOOK




ANGUS ALPHA ................................. 41 AMERICAN LEGEND .......... 21 AMPLIFY ............................. 40 ATLANTIS............................ 16 ATTRACTIVE ....................... 10 BRUTUS .............................. 12 CACHE ................................. 27 CASCADE ............................ 38 CASH FLOW ........................ 39 COLOSSAL ......................... 8 COLUMBUS ......................... 28 COMET ................................. 19 ELECTRIFY .......................... 43 ELEVATION ......................... 36 ENDORSE ............................ 40 EXPEDITION ....................... 42 EXPRESSION ...................... 15 HIGH COTTON .................... 33 HIGH VALUE ....................... 43 IMMENSITY......................... 45 JESSE JAMES .................... 23 LAWMAN ............................. 35 MAGNIFY............................. 25 MAXIMA .............................. 32 MOGUL ................................ 13 MONEYBALL ....................... 44 NEVADA .............................. 17 OUTLIER.............................. 18 OVERHAUL ......................... 31 PILLAR ................................ 34 POTENT ............................... 26 PREFERENCE ..................... 47 PROFOUND ......................... 7 QUEST ................................. 42 RAIN MAKER ...................... 22 RENEGADE .......................... 42 RENOVATION ...................... 9 SILVER STAR ...................... 46 SOUTH DAKOTA ................. 39 SPECIALIST ........................ 20 STOCK FUND ...................... 14 TANKER ............................... 11 TENDERLOIN ...................... 37 TOWNSHIP .......................... 30 TRUST ................................. 24 UPGRADE ............................ 48 VEZINA ................................ 29 RED ANGUS CUSTOM MADE .................. 56 FURY .................................... 54 MOSSY OAK ........................ 51 OUTCOME ........................... 53 PAYLOAD............................. 50 RAZOR ................................. 55 ROCKEFELLER ................... 52 SIMMENTAL AFFINITY............................. 62 ASSET .................................. 60 BANK ROLL ........................ 68 BOUNTY HUNTER.............. 64 DIMENSION ........................ 63 EPIC ..................................... 58 GREAT WESTERN............... 65 GROWLER ........................... 65 HEXTOR ............................... 70 POL EDDY ........................... 67 ROCKET ............................... 69 SENSATION......................... 66 STATE OF WAR ................... 61 TRUE NORTH...................... 59 ULTRA INDEPENDENCE .... 71 CHAROLAIS BACKWATER JACK ............ 83 BADGE ................................. 76 BLUEPRINT ......................... 82 CASINO ............................... 85 DEL REY .............................. 77 GRIFFIN ............................... 81 LEVEL UP ........................... 79 RAMPART ............................ 80 TRIED AND TRUE............... 74 TRIUMPH ............................ 73 VAN HALEN ........................ 84 WHEATON ........................... 75 YELLOWSTONE .................. 78 HEREFORD BIG COUNTRY .................... 88 BOLDER ............................... 87 BUCCANEER ....................... 90 EXPLORER .......................... 89 RIB EYE ............................... 92 ULTIMATE ........................... 91 SHORTHORN BIG TICKET ......................... 96 FLASH ................................. 95 PHANTOM ........................... 94 LIMOUSIN CAMDEN .............................. 99 FORMATION ........................ 100 GRASS ROOTS .................... 98 HALIBUT ............................. 101 HANG UP............................. 101 HAWTHORNE ...................... 101 SPECKLE PARK EXTREME ........................... 103 JUDGEMENT CALL ............ 102 MATTERS ............................ 103 TRADE SECRET .................. 103 BLONDE D’AQUITAINE SUPREMACY....................... 104 BRITISH BLUE MARIO ................................. 105 MONSTER MUNCH ............ 105 ORION.................................. 105 GELBVIEH RESILIENT .......................... 106 WAGYU KOMAKI ............................... 107 KUNE ................................... 107 SANMARRO ........................ 107

Dennis Serhienko
Beef Sire Acquisition and Product Support

t: (306) 389-7770
dserhienko@semex.com
Brad Gilchrist

Beef Marketing Manager


t: (519) 440-6720
bgilchrist@semex.com
SEMEX GLOBAL HEADQUARTERS
5653 Highway 6 North, Guelph, ON N1H 6J2
t: (519) 821-5060 | f: (519) 821-7225 | beef@semex.com | www.semex.com
SEMEX INTERNATIONAL SUBSIDIARIES
ARGENTINA
t: 54-11-4-305-0101 | inseminacion@semex.com.ar
Augusto Jordan | augustoj@semex.com.ar
AUSTRALIA
t: 03 974 0344 | David Mayo
davidmayo@semex.com.au
Maria Dickson | mdickson@semex.com.au
BRAZIL
t: 55-47-3231-0400 | Nelson Eduardo Ziehlsdorff nelson@semex.com.br
Antonio Carlos Sciamarelli Jr. antonio.carlos@semex.com.br
Kayla Walker
Beef Specialist
t: (519) 821-5060 ext. 1706 kwalker@semex.com
CHINA
t: 021-60296615-804 | Xiaoliang Tangr xtang@semex.com
GERMANY
t: 49-4231-95330 | Martin Buschsieweke m.buschsieweke@semex-deutschland.de
HUNGARY
t: 36-68-566-200 | Zoltán Veres zveres@semex.hu
MEXICO
t: 4741166186 / 4741166188
Ernesto Padilla De Anda | eanda@semex.com
NEW ZEALAND
t: 07 899 1572 | David Mayo
davidmayo@semex.com.au
UNITED KINGDOM
t: 44 (1292) 671-525 | Michael Dennison
michael@semex.co.uk
USA PO Box 8280, Madison, Wisconsin 53708
t: (800) 303-BULL (2855) | f: (608) 838-3667
e: info@semexusa.com
7660 Mill Road, Guelph, ON N1H 6J2
t: 1-888-821-2150 e: info@eastgen.ca www.eastgen.ca
Regional Coordinators
Ontario:
Atlantic Canada:
Semen Orders:
Scott Cornish
t: 705-878-3248
scott.cornish@eastgen.ca


Dale MacPhee
t: 506-875-1573
dale.macphee@eastgen.ca
Lori Brunskill
t: 1-888-821-2150 (Ext. 253)
lori.brunskill@eastgen.ca
To ensure timely delivery, please order semen well in advance.

WESTERN CANADA’S GENETIC CENTRE
DISTRIBUTORS
WestGen Head Office
ABBOTSFORD, BC | (800) 563-5603
BRITISH COLUMBIA
Chris Maher | East Fraser Valley | (604) 626-7396
Greg Hessels | West Fraser Valley/Island | (604) 626-8748
Phil Hemphill | Lower Mainland | (604) 302-2063
Kurtis Severinski | Interior | (250) 463-2052
ALBERTA
Neil Hazel / Wild Rose Reproductive / 403-586-5570
Jenine Ruzicka | Killam | (780) 336-4919
Clint Morasch | Bassano | (403) 793-1656
Erin Rey | Central AB | (403) 704-0243
John Muller | Southern AB | (403) 394-8530
Reed Rigney | Westlock, AB | (780) 348-5308
Carson Klugkist | Northern AB | (403) 597-1148
SASKATCHEWAN
Rob McNabb | Glenbush | (306) 883-7995
Cam Morgan | Saltcoats | (306) 744-7411
Dennis Serhienko

Beef Program Manager t: (306) 389-7770
dserhienko@westgen.com
Paul Meyer WestGen Sales Manager t: (778) 227-0360
pmeyer@westgen.com
Ashley Shannon | Mortlach | (306) 631-4019
Grant Scheirlinck | Blumenhof | (306) 741-8398
Leroy Steinhubl | Balgonie/Kronau | (306) 536-1784
Mike Franc, Alliance Genetics | Prince Albert | (306) 930-8684
Ian Hodges | Saskatchewan | (306) 260-0330



MANITOBA
Darrel Barkman | (204) 346-2719
Ben Loeppky | (204) 750-1498
Stephane Robidoux | (204) 770-6639
Blair & Lois McRae | (204) 728-3058
ANGUS

PROFOUND
TEHAMA REVERE
S POWERPOINT WS 5503
0200AN10796 | ELLINGSON PROFOUND 8155 | $65
S QUEEN ESSA 248
CONNEALY CAPITALIST 028
EA ROSETTA 6157
EA BLACKBIRD 0038
• Crowd favorite, and top selling bull from the 2019 Ellingson Angus sale, regarded as one of the greatest sires to come out of the Ellingson program


• Sons were headliners in both Peak Dot and Ellingson Angus 2022 bull sales

• Weaned off his two year old dam at 930 lbs then matured into a power packed, muscular, high volume individual and one of the strongest-footed sires we’ve come across
19203612 2018-02-256.0yrl78lbs911lbs1400lbs44.0cmyrl
2087909 8155matRatio--Ratio--Ratio----cmmat
Reg# 2087909
BD: February 25, 2018
Frame: 6.0
AAA-W22CEDBWWWYWRADGDMIYHSCDOCCLAWANGLEPAPHPCEMMILKMKHMWMH$EN
BW: 78 lbs
WW: 911 lbs
YW: 1428 lbs
Scrotal: 44 cm
9 | ANGUS 9 |
REG.#BORNFRAMEBWWWYWSCROTAL
EPD 43.6831270.211.040.31.08200.090.161.3812.3511241-0.1-1 ACC 0.510.850.850.810.390.390.520.690.770.690.630.260.450.550.470.440.45 RANK% 709552075607035401160408095708520 AAA-W22CWMARBREFAT$M$F$G$B$C EPD 500.280.490.0291018132113248 ACC 0.480.410.420.41 RANK% 35806075160807535
Dot
Progeny at Ellingson Angus Progeny at Peak
Ranch
Owned with Peak Dot Ranch & Ellingson Angus
COLOSSAL
CONNEALY CAPITALIST 028
LD CAPITALIST 316
0200AN10737 | MUSGRAVE 316 COLOSSAL 137 | $30
LD DIXIE ERICA 2053
MUSGRAVE BIG SKY
MUSGRAVE LADY BARBARA 545
MUSGRAVE LADY BARBARA 272
• Unmatched body mass and rib shape rarely seen in a top ranking proven calving ease sire and progeny data is reinforcing his strong CE numbers
• Maternal lineage has many generations of high fertility, strong footed, and great uddered females. His first daughters in production are outstanding!
• From one of the most sought after bulls in the 2018 bull sale season, Colossal has matured into one of the most impressive mature calving ease sires in the Angus breed



Reg# 2021884
BD: January 4, 2017
Frame: 5.6
BW: 70 lbs
WW: 878 lbs
YW: 1376 lbs
Scrotal: 40
10 | ANGUS 10 |
Dam - MUSGRAVE LADY BARBARA 545
Progeny at Peak Dot Ranch
REG.#BORNFRAMEBWWWYWSCROTAL 18774441 2017/01/045.6yrl70lbs878lbs1376lbs40.0cmyrl 2021884 137--matRatio95Ratio108Ratio107--cmmat AAA-W22CEDBWWWYWRADGDMIYHSCDOCCLAWANGLEPAPHPCEMMILKMKHMWMH$EN EPD 13-1.2611020.240.43-0.40.07190.340.390.510.514192531-0.4-1 ACC 0.810.920.890.830.420.420.660.680.500.410.430.310.300.650.610.530.47 RANK% 1010506050209590404103565590809520 AAA-W22CWMARBREFAT$M$F$G$B$C EPD 380.890.570.032808362145268 ACC 0.520.450.460.45 RANK% 652050801055203520
Dot
cm
Owned with Peak
Ranch
RENOVATION
RITO 707 OF IDEAL 3407 7075
S A V RENOWN 3439
0200AN10734 | S A V RENOVATION 6822 | $65
S A V BLACKCAP MAY 4136
S A V 004 DENSITY 4336
S A V MADAME PRIDE 0151
S A V MADAME PRIDE 0075
• Must-use sire for breeders wanting to improve maternal traits along with an easy fleshing, solid body composition


• Rock solid genetics combining industry noted female makers; Renown and Density. Renovation daughters are setting the new standard!
• In 2021 at Schaff Angus Valley, Renovation sons average $46,277 with high sellers at $185,000 & $140,000
REG.#BORNFRAMEBWWWYWSCROTAL
18579309 2016/01/285.9yrl76lbs905lbs1625lbs39.0cmyrl
1963240 6822--matRatio100Ratio100Ratio100--cmmat
• Brooking Angus 2021 top Renovation sons were $60,000 & $47,500

Reg# 1963240
BD: January 28, 2016
Frame: 5.9
AAA-W22CEDBWWWYWRADGDMIYHSCDOCCLAWANGLEPAPHPCEMMILKMKHMWMH$EN
BW: 76 lbs
Dam - S A V MADAME PRIDE 0151
WW: 905 lbs
YW: 1625 lbs
Scrotal: 39 cm
11 | ANGUS
11 |
EPD 52.3711250.241.510.41.08190.390.371.968.23184951-0.1-10 ACC 0.690.920.900.810.340.340.750.740.580.270.270.130.210.670.600.380.33 RANK% 65752025508560354010570859090608535
EPD 400.40.270.089677830108207 ACC 0.430.350.410.36
606590953065858075
AAA-W22CWMARBREFAT$M$F$G$B$C
RANK%
Progeny of Renovation
Owned with Brooking Angus and Schaff Angus Valley
ATTRACTIVE
0200AN10728 | SCHIEFELBEIN ATTRACTIVE 4565 | $35
SITZ TOP GAME 561X
JMB TRACTION 292
JMB EMULOTA 013
S A V FINAL ANSWER 0035
FROSTY ANSWER 3979
FROSTY ELBA LIZZY 1106
• One of the most popular individuals with breeders across the globe when viewed in stud due to his stout-featured and massive body design, with tremendous foot shape and heel depth


• Sale topping sons at $125,000, $70,000 & $60,000

• Genomic ranking in the top 10% or higher for WW, YW and Milk
• Positive scan data posting a 116 ratio for IMF
18272797 2015/03/206.2yrl85lbs860lbs1484lbs37.0cmyrl
1938699 4565--matRatio89Ratio117Ratio109--cmmat
Reg# 1938699
BD: March 20, 2015
Frame: 6.2
AAA-W22CEDBWWWYWRADGDMIYHSCDOCCLAWANGLEPAPHPCEMMILKMKHMWMH$EN
BW: 85 lbs
3979
WW: 860 lbs
YW: 1484 lbs
Scrotal: 37 cm
12 | ANGUS 12 | REG.#BORNFRAMEBWWWYWSCROTAL
EPD 52.6861540.291.860.80.87310.460.421.8510.763327800.6-31 ACC 0.700.920.890.810.440.440.760.710.660.610.610.290.330.660.630.620.69 RANK% 658033159520503352070607515252585
EPD 500.660.55-0.007788654140260 ACC 0.530.460.470.46
353555251050354025
ANSWER
AAA-W22CWMARBREFAT$M$F$G$B$C
RANK%
Dam - FROSTY
Progeny of Attractive
Owned with Peak Dot Ranch and Schiefelbein Angus Farm
TANKER
KM BROKEN BOW 002
CASINO BOMBER N33
0200AN10804 | LVVF TANKER 14 | $ 45
CASINO ANNIE K48
V A R LEGEND 5019
LVVF LEGEND 842
LVVF BULLSEYE 1154
• Exciting new sire! One of the real highlight individuals of the 2022 sale season
• Tanker is a massive-bodied, wide and deep made individual that had a yearling scan day weight of 1602 lbs and a 42.5 cm scrotal
• Tanker combines top ranking EPDs, phenotype, muscle, capacity and soundness with fertility and performance, all set on great feet with strong heel depth and excellent claw shape.


• His dam is backed by two consecutive generations of Pathfinder dams
Reg# 20132190
BD: January 7, 2021
Frame: -
Sire - CASINO BOMBER N33
BW: 84 lbs
WW: 842 lbs
YW: 1592 lbs
Scrotal: 43 cm
EPD 60.8951720.332.531.21.32270.340.354.3816.8291301.4 ACC 0.350.540.470.420.320.321.200.400.350.290.290.290.260.330.380.39 RANK% 5540114953251544951085302195 AAA-W22CWMARBREFAT$M$F$G$B$C EPD 910.751.1-0.0287813467201339 ACC 0.410.370.370.34 RANK% 1353101511511 13 | ANGUS 13 |
Owned with Peak Dot Ranch REG.#BORNFRAMEBWWWYWSCROTAL 20132190 01/07/2021yrl84lbs842lbs1592lbs42.5cmyrl matRatio40Ratio1Ratio1cmmat AAA-W22CEDBWWWYWRADGDMIYHSCDOCCLAWANGLEPAPHPCEMMILKMKHMWMH$EN
0200AN10112 | BROOKDALE BRUTUS 390 | $50
EF COMMANDO 1366
BALDRIDGE BRONC
BALDRIDGE ISABEL Y69
S A V RESOURCE 1441
BROOKDALE JODIE 786
BROOKDALE JODIE 73
• One of the most exciting and highly regarded sires to enter stud in 2021
• Backed by a highly maternal cow family with two of the most influential cows in the entire Angus breed making up his pedigree; Baldridge Isabel Y69 and S A V Blackcap May 4136


• The heaviest weaning and yearling weight bull of Brookdale’s entire calf crop along with the highest IMF scan

19854629 2020-01-236.0yrl85lbs894lbs1514lbs42.0cmyrl 390--matRatio100.0Ratio100.0Ratio100.0cmmat
Reg# 19854629
BD: January 23, 2020
Owned with Peak Dot Ranch & Scott Metzger
AAA-W22CEDBWWWYWRADGDMIYHSCDOCCLAWANGLEPAPHPCEMMILKMKHMWMH$EN
Frame: 6.0
PGD - BALDRIDGE ISABEL Y69
BW: 85 lbs
WW: 860 lbs
YW: 1514 lbs
Scrotal: 41 cm
4136
14 | ANGUS 14 |
REG.#BORNFRAMEBWWWYWSCROTAL
721031670.232.260.51.2660.350.460.3816.3828990.2-38 ACC 0.530.780.730.410.360.360.550.490.380.300.290.290.260.330.340.400.43
457011609550259043530105535106095
EPD 640.60.690.064888647134262 ACC
EPD
RANK%
AAA-W22CWMARBREFAT$M$F$G$B$C
0.460.390.400.37
RANK% 10403595350455025 S A V BLACKCAP MAY
BRUTUS
MOGUL
KM BROKEN BOW 002
SPRING COVE RENO 4021
0200AN10840
19502726 2019-01-28yrl65lbs649lbs39.0cmyrl
2233520 G241matRatio100.0Ratio100.0cmmat
AAA-W22CEDBWWWYWRADGDMIYHSCDOCCLAWANGLEPAPHPCEMMILKMKHMWMH$EN
SPRING COVE LIZA 021
BALDRIDGE XPAND X743
BALDRIDGE ISABEL C773
BALDRIDGE ISABEL Y69
• Exciting new sire who offers multi-trait excellence with a powerful phenotype


• Top of charts foot EPDs with exceptional carcass merit and leading growth lending to top 1% $Maternal, 5% $Beef and 1% $C rankings
• Dam is a direct daughter of the famed Baldridge Isabel Y69, and is a leading donor in the Reverse Rocking R Ranch program

• Mogul offers great mating flexibility with his rock solid phenotype and leading data package, reinforced with maternal excellence
Reg# 2233520
BD: January 28, 2019
Frame: -
BW: 65 lbs
WW: 649 lbs
YW: - lbs
Scrotal: 39 cm
15 | ANGUS 15 |
REG.#BORNFRAMEBWWWYWSCROTAL
EPD 70.5781420.321.30.70.78170.220.362.5115.21237590.5-24 ACC 0.340.490.420.380.310.310.450.400.370.300.300.260.260.330.330.380.38 RANK% 45351010570355555158020153604070 AAA-W22CWMARBREFAT$M$F$G$B$C EPD 591.011.17-0.0589710083183334 ACC 0.380.350.350.31 RANK% 251521120351 Full Sibling - PV ISABEL G204 MGD - BALDRIDGE ISABEL Y69
| PINE VIEW MOGUL G241 | $35
STOCK FUND
BASIN PAYWEIGHT 1682
DEER VALLEY GROWTH FUND
0200AN10783 | GVC STOCK FUND 038H | $25
DEER VALLEY RITA 36113
V A R LEGEND 5019
GVC DESIREE F024
G A R DAYBREAK 1402
• Curve bender deluxe, starting out with a 74 lb BW performing to an 840 lb 205 day weight in Nebraska ranch country
• Extra body and mass with “pounds in all the right places,” Stock Fund is a keen-headed individual who is smooth-made, yet full-featured and powerful in his design
• This EPD superstar’s donor dam sports an excellent udder with small teat size



19882325 2020-02-14yrl74lbs920lbs1403lbs37.5cmyrl
2199000 038H--matRatio100.0Ratio100.0Ratio100.0cmmat
Reg# 2199000
BD: February 14, 2020
Frame: 6.2
AAA-W22CEDBWWWYWRADGDMIYHSCDOCCLAWANGLEPAPHPCEMMILKMKHMWMH$EN
BW: 74 lbs
WW: 840 lbs
YW: 1403 lbs
Scrotal: 38 cm
16 | ANGUS 16 | REG.#BORNFRAMEBWWWYWSCROTAL
EPD 17-1.7861550.321.7310.68250.490.53.113.417361170.8-50 ACC 0.340.500.430.380.320.320.440.400.360.290.290.270.250.320.320.370.40 RANK% 1532590106520456090351451595
EPD 691.170.650.0376510876183302 ACC 0.400.370.360.32
1010458545101055 Dam
GVC DESIREE
Sire
AAA-W22CWMARBREFAT$M$F$G$B$C
RANK%
-
F024
- DEER VALLEY GROWTH FUND
Owned with Green Valley Cattle
EXPRESSION
SMA WATCHOUT 482
CONLEY EXPRESS 7211
0200AN10358 | CONLEY EXPRESSION 9213 | $50
DPL SANDY 3040
P R BLACK FRIDAY 0244
DOUBLE R BAR PURE PRIDE Z246
BOHI PURE PRIDE 6096
• Powerfully designed with superior phenotype and an exceptional look
• His donor dam, Double R Bar Pure Pride Z246, is the preeminent donor in the Conley program with numerous sale toppers and show winners to her credit



• Expression was the lead off Lot 1 in the 2020 Conley sale and gathered much admiration and attention while on display in Denver 2020
19550995 2019/02/245.8yrl82lbs1390lbs37cmyrl
2168889 9213--matRatio--Ratio--Ratio----cmmat
Reg# 2168889
BD: February 24, 2019
Owned with Conley Cattle
AAA-W22CEDBWWWYWRADGDMIYHSCDOCCLAWANGLEPAPHPCEMMILKMKHMWMH$EN
EPD -34.8651060.270.210.50.36180.410.361.536.8-2181080.6-36 ACC 0.330.580.450.360.280.280.420.390.310.220.220.210.170.280.290.330.36
RANK% 95953555301550804515460959590102595
AAA-W22CWMARBREFAT$M$F$G$B$C
EPD 380.30.53-0.026258738126188
ACC 0.360.320.320.28
RANK% 657555109550656085
Frame: 5.8
BW:
Dam - DOUBLE R BAR PURE PRIDE Z246
WW:
YW:
Scrotal: 37 cm
Full Sibling of Expression at Conley
17 | ANGUS 17 |
REG.#BORNFRAMEBWWWYWSCROTAL
ATLANTIS
COLEMAN CHARLO 0256
S A V RAINFALL 6846
271AN4775 | SQUARE B ATLANTIS 8060 | $65
S A V BLACKCAP MAY 4136
CONNEALY CONSENSUS
ELBANNA OF CONANGA 1209
ELBASTA OF CONANGA 9703
• Rock solid genetics covering all the bases and checking all the boxes!
• Highly maternal sire with top level docility and foot quality in a stout made, and powerfully built body type with an abundance of mass and volume in an eye pleasing package
• Produced from the $125,000 pick of the Connealy Angus females



19405249 2018/08/245.5yrl84lbs711lbs1169lbs--cmyrl
2192495 8060--matRatio--Ratio--Ratio----cmmat
Reg# 2192495
BD: August 24, 2018
Frame: 5.5
AAA-W22CEDBWWWYWRADGDMIYHSCDOCCLAWANGLEPAPHPCEMMILKMKHMWMH$EN
BW: 84 lbs
WW: 711 lbs
YW: 1169 lbs
Scrotal: -
18 | ANGUS
REG.#BORNFRAMEBWWWYWSCROTAL
EPD 70.6561030.280.4-0.21.21230.340.521.116.442435-0.2-5 ACC 0.620.920.880.810.420.420.790.790.730.590.580.290.370.340.350.460.45 RANK% 45356060202095252547050108560759025
EPD 250.610.870.012826754122240 ACC 0.520.460.470.47 RANK% 854015501085356545
at Montana Ranch LLC Dam - ELBANNA OF CANANGA 1209
AAA-W22CWMARBREFAT$M$F$G$B$C
Progeny
Montana Ranch LLC
Owned by Beartooth Angus and
NEVADA
KM BROKEN BOW 002
SPRING COVE RENO 4021
0200AN10360 | RAVEN NEVADA G100 | $35
SPRING COVE LIZA 021
PA VALOR 201
RAVEN BLACKBIRD BLACKIE E300
RAVEN BLACKBIRD BLACKIE 1241
• Phenotypically appealing individual being attractive in his look, sound-structured in his build, and massive in his design
• Outstanding son of the popular and deceased Spring Cove Reno
• Exceptional 156 Marbling index while also having the largest actual Ribeye scan of all his contemporaries to index 116 REA
19507360 2019/01/14yrl90lbs830lbs1400lbs41.0cmyrl
2141813 G100matRatio108.0Ratio123.0Ratio115.0--cmmat
Reg# 2141813
BD: January 14, 2019
Owned with Raven Angus



Frame: -
AAA-W22CEDBWWWYWRADGDMIYHSCDOCCLAWANGLEPAPHPCEMMILKMKHMWMH$EN
BW: 90 lbs
WW: 911 lbs
YW: 1409 lbs
Scrotal: 41 cm
19 | ANGUS 19 | REG.#BORNFRAMEBWWWYWSCROTAL
EPD 121.1801350.221.670.91.2180.450.512.04181225560.5-16 ACC 0.530.700.550.470.340.340.470.540.350.290.290.250.250.320.330.390.40 RANK% 15501015659015254530607531555553550
EPD 591.031.010.004959277169314 ACC 0.430.380.390.36 RANK% 201054013510153 Sire
SPRING
PGD
SPRING
LIZA
AAA-W22CWMARBREFAT$M$F$G$B$C
-
COVE RENO 4021
-
COVE
021
OUTLIER
BENNETT ABSOLUTE
HAYNES OUTRIGHT 452
0200AN10109 | HART OUTLIER 7033 | $30
HAYNES ND 454 MISS 179
E&B BLACKJACK 321
HART LIBERTY BELLE 5315
HART LIBERTY BELLE 2625
• High performance bull with moderate birth and CE EPDs



• Performance ranking in the top 10% YW, top 15% WW and 20% CW
• Outcross pedigree with standout figures across the board
18942501 2017/01/276.1yrl79lbs829lbs1527lbs42.7cmyrl
2021909 7033--matRatio105Ratio113Ratio118--cmmat
Reg# 2021909
BD: January 27, 2017
Frame: 6.1
Owned with Hart Angus
AAA-W22CEDBWWWYWRADGDMIYHSCDOCCLAWANGLEPAPHPCEMMILKMKHMWMH$EN
BW: 79 lbs
WW: 829 lbs
YW: 1527 lbs
Scrotal: 43 cm
K C F
20 | ANGUS 20 | REG.#BORNFRAMEBWWWYWSCROTAL
EPD 90.6751440.311.790.61.9330.50.432.149.610212940.6-31 ACC 0.450.680.590.490.360.360.480.520.350.280.280.280.250.360.370.400.41 RANK% 3035151010954042502075703580152585
EPD 580.580.410.0525910444148251 ACC 0.440.400.390.37
204575955020503535
AAA-W22CWMARBREFAT$M$F$G$B$C
RANK%
Sire - HAYNES OUTRIGHT 452 Progeny at Arntzen Angus
COMET
FIRE 6404
GB FIREBALL 672
0200AN10800 | CUDLOBE COMET 91J | $30
GB ANTICIPATION 432
FF EZ MONEY D217
CUDLOBE ENCHANTRESS 109G
CUDLOBE ENCHANTRESS 5B
• Curve bender deluxe! Comet provides top-ranked calving ease and performance in an upscale maternal package with elite carcass figures
• Cudlobe Angus sale headliner regarded as one of the top sires produced to date



• Added body dimension and length with pleasing conformation
REG.#BORNFRAMEBWWWYWSCROTAL
2021/01/15yrl69lbs831lbs1548lbscmyrl
2203858 matRatio84.0Ratio113.0Ratio113cmmat
• His great-uddered dam is a pasture favourite
Reg# 2203858
BD: January 15, 2021
Frame: -
CAA-W22CEDBWWWYWRADGDMIYHSCDOCCLAWANGLEPAPHPCEMMILKMKHMWMH$EN
EPD 121.6861640.371.911.56280.530.512261281.1
ACC 0.370.540.460.420.330.330.470.330.300.300.210.290.350.37
RANK% 440111994385652512
CAA-W22CWMARBREFAT$M$F$G$B$C
EPD 721.160.89-0.009
ACC 0.400.350.350.31
RANK% 12310
BW: 69 lbs
WW: 831 lbs
YW: 1548 lbs
Scrotal: -
G A R SURE
PGS - G A R SURE FIRE
Sire - GB FIREBALL 672
6404
21 | ANGUS 21 |
SPECIALIST
EF COMMANDO 1366
0200AN10760 | MOGCK SPECIALIST 98 | $30
BALDRIDGE 38 SPECIAL BALDRIDGE ISABEL Y69
STYLES CASH R24
MOGCK RUTH 1686
MOGCK RUTH 264
• Curve bending calving ease sire with top level performance



• Actual data backs up genomic data with BW ratio 86, WW ratio 111 and YW ratio 106
• Rock solid proven calving ease with performance in a powerful and well-built body design
19316692 2017/12/235.8yrl65lbs839lbs1372lbs40.0cmyrl
2079512 98--matRatio86Ratio111Ratio106--cmmat
Reg# 2079512
BD: December 23, 2017
Owned with Mogck & Sons
AAA-W22CEDBWWWYWRADGDMIYHSCDOCCLAWANGLEPAPHPCEMMILKMKHMWMH$EN
Frame: 5.8
- BALDRIDGE 38 SPECIAL
BW: 65 lbs
WW: 839 lbs
YW: 1372 lbs
Scrotal: 40 cm
- BALDRIDGE ISABEL Y69
22 | ANGUS 22 | REG.#BORNFRAMEBWWWYWSCROTAL
EPD 11-2.7711270.241.710.51.22330.380.440.7114.194029-0.1-11 ACC 0.500.700.560.440.330.330.450.480.330.270.270.220.240.300.320.380.40 RANK% 152252055905530210304030451909035
EPD 450.770.410.0691027651127267 ACC 0.400.360.360.34
55358095170456525 Sire
PGD
AAA-W22CWMARBREFAT$M$F$G$B$C
RANK%
AMERICAN LEGEND
0200AN10785 | S A V AMERICAN LEGEND 0029 | $30
S A V PRESIDENT 6847
S A V AMERICA 8018
S A V MADAME PRIDE 0075
S A V 004 DENSITY 4336
S A V EMBLYNETTE 3293
S A V EMBLYNETTE 7411
• The only America son in the entire breed with his elite curve bender stats of -0.4 BW to 114 YW, as well as having the lowest BW EPD of the entire S A V 2021 sale offering



• At the very top of the list with breeders looking for a calving ease sire with more mass and dominating body shape
19852823 2020-02-18yrl67lbs1085lbs1473lbs40.1cmyrl
2206294 29matRatio78.0Ratio107.0Ratio101.0cmmat
Reg# 2206294
BD: February 18, 2020
Owned with Schaff Angus Valley
AAA-W22CEDBWWWYWRADGDMIYHSCDOCCLAWANGLEPAPHPCEMMILKMKHMWMH$EN
Frame: -
- S A V AMERICA 8018
BW: 67 lbs
WW: 991 lbs
YW: 1473 lbs
Scrotal: 40 cm
3293
23 | ANGUS 23 |
REG.#BORNFRAMEBWWWYWSCROTAL
EPD
ACC 0.190.380.350.330.190.190.290.390.370.160.160.050.110.200.190.200.18 RANK% 452020407555451530303520407590354070
EPD 470.460.680.029667543118219 ACC
507040754570658075
Dam
7-0.4721140.221.090.61.59230.450.45I-.0413620780.5-23
AAA-W22CWMARBREFAT$M$F$G$B$C
0.250.220.260.22 RANK%
Sire
- S A V EMBLYNETTE
RAINMAKER
DIAMOND RAINMAKER 129A
HILLTOP RAINMAKER 6274
0200AN10771 | DL RAINMAKER 1879 | $35
HILLTOP GOLD JESTRESS 9115
DL FINAL GRANDVIEW 53
DL RUBY 496
DL RUBY 1491
• Outcross powerhouse who has caught the attention of breeders worldwide due to his bold and imposing body design coupled with a fresh outcross pedigree, backed by a highly productive dam
• Impressive Growth, Scrotal, Docility & Ribeye with strong foot size and shape



• Very positive progeny reports coming in from across the globe
19590305 2019/02/135.8yrl73lbs850lbs1387lbs41.6cmyrl
2138835 --matRatio94Ratio106Ratio111--cmmat
Reg# 2138835
BD: February 13, 2019
Frame: 5.8
CAA-W22CEDBWWWYWRADGDMIYHSCDOCCLAWANGLEPAPHPCEMMILKMKHMWMH$EN
EPD 23.7901520.321.12.64240.470.4210201591.2
ACC 0.360.670.530.400.290.290.460.420.300.300.140.260.320.35
RANK% 65801117511060157511
CAA-W22CWMARBREFAT$M$F$G$B$C
EPD 780.220.940.005
ACC 0.360.290.300.26
RANK%
BW: 70 lbs
WW: 849 lbs
YW: 1387 lbs
Scrotal: 42 cm
Maternal Sibling to Rainmaker
24 | ANGUS 24 |
REG.#BORNFRAMEBWWWYWSCROTAL
Dam - DL RUBY 496
JESSE JAMES
S A V RENOWN 3439
S A V RENOVATION 6822
316AN0181 | S A V JESSE JAMES 0968 | $65
S A V MADAME PRIDE 0151
S A V 8180 TRAVELER 004
S A V BLACKCAP MAY 8961
S A V MAY 2397
• Schaff Angus Valley Sale Headliner with stellar phenotype, powerful performance, herd-changing properties and breed-impacting potential
• S A V Jesse James is in a phenotypic class of his own, demonstrating power, presence and structural balance in every step he takes
REG.#BORNFRAMEBWWWYWSCROTAL 19860276 2019/12/22yrl83lbs938lbs1538lbs42.7cmyrl
968matRatio100.0Ratio100.0Ratio100.0cmmat
• His proven 13-year-old pathfinder dam, S A V Black May 8961, is a full sister to the legendary S A V Blackcap May 4136 and on the same path to productivity



Reg# 19860276
BD: December 22, 2019
Casey Green
AAA-W22CEDBWWWYWRADGDMIYHSCDOCCLAWANGLEPAPHPCEMMILKMKHMWMH$EN
Frame:
BW: 83 lbs
2158
WW: 938 lbs
YW: 1538 lbs
Scrotal: 43 cm
25 | ANGUS 25 |
- S A V
MAY 8961
Son - S A V GUNSMOKE
Dam
BLACKCAP
Owned by Schaffs Angus Valley, Cole Elrod,
EPD 91.955950.210.80.21.46130.320.351.288.4821570-14 ACC 0.330.690.560.280.210.210.330.400.370.120.120.080.100.240.230.210.20 RANK% 3065657075458015702355855580557545 AAA-W22CWMARBREFAT$M$F$G$B$C EPD 340.350.110.0755702797181 ACC 0.310.230.280.23 RANK% 707095956580909090
TRUST
CONNEALY EARNAN 076E
ELINGSON ROUGHRIDER 4202
EA BLACKLASS 8914
HOOVER NO DOUBT
PEAK DOT QUEEN 303D
QUEEN OF PEAK DOT 903W
• Absolute standout sire acclaimed to be the most powerful sire ever produced in the Peak Dot Ranch program

• Big-topped and square-hipped, with massive volume and muscle dimension combined with breed leading growth and carcass figures
• Powerful pedigree steeped in outstanding phenotype being an Ellingson Roughrider 4202 x Hoover No Doubt


19805406 2019/01/256.1yrl80lbs895lbs1425lbs39cmyrl
2111614 86G--matRatio--Ratio--Ratio----cmmat
Reg# 2111614
BD: January 25, 2019
Owned
Peak Dot Ranch
AAA-W22CEDBWWWYWRADGDMIYHSCDOCCLAWANGLEPAPHPCEMMILKMKHMWMH$EN
Frame: 6.1
BW:
303D
WW:
YW:
26 | ANGUS MGD - QUEEN OF PEAK DOT 903W 26 |
REG.#BORNFRAMEBWWWYWSCROTAL
EPD 31.8561060.270.750.51.27220.460.381.5610.11225650.2-20 ACC 0.390.760.660.460.330.330.480.400.350.290.290.210.250.310.340.370.40 RANK% 806565553030552535351060751560507060 AAA-W22CWMARBREFAT$M$F$G$B$C EPD 530.480.60.041569942142240 ACC 0.420.350.360.31 RANK% 356555857020654550 Dam
PEAK DOT QUEEN
-
| PEAK DOT TRUST 86G | $30
0200AN10775
Scrotal: 39 cm with
MAGNIFY
3F EPIC 4631
EXAR MONUMENTAL 6056B
0200AN10784 | GVC MAGNIFY 002H | $30
FWY 7008 OF C085 4029
VINTAGE LEGACY 4409
GVC PRINCESS F097
GVC PRINCESS Y08
• Powerful and heavy-structured
• Amazing growth, Marbling and Ribeye all wrapped up in a wide based, massive-built package

• Will substantially move all growth and carcass traits in a positive direction
REG.#BORNFRAMEBWWWYWSCROTAL
19882405 2020-01-20yrl95lbs847lbs1306lbs34.2cmyrl
2198965 002HmatRatio119.0Ratio114Ratio107cmmat
Reg# 2198965
BD: January 20, 2020
Frame: -
AAA-W22CEDBWWWYWRADGDMIYHSCDOCCLAWANGLEPAPHPCEMMILKMKHMWMH$EN
BW: 87 lbs
Sire - EXAR MONUMENTAL 6056B

WW: 847 lbs
YW: 1306 lbs
Scrotal: 34 cm
27 | ANGUS 27 |
EPD 14.51031760.292.690.90.69280.60.552.3110.79201531.4-58 ACC 0.370.530.460.410.320.320.440.470.330.280.280.260.230.310.320.370.39 RANK% 90951120951565109080757045901195 AAA-W22CWMARBREFAT$M$F$G$B$C EPD 841.331.090.0194611891208316 ACC 0.410.360.360.32 RANK%
04112 Owned with Green Valley Cattle
133609
POTENT
BRILLIANCE 8077
PVF INSIGHT 0129
0200AN10836 | RAML POTENT 8427 | $25
PVF MISSIE 790
S A V FINAL ANSWER 0035
RAML RUBY 427
RAML RUBY 105
• Has the look!
• High growth son of Insight with a tremendous amount of eye appeal
• One of the most talked about sires in the 2019 spring bull sale season


• Used to add performance data while maintaining an attractive body type
19334052 2018/01/066.3yrl88lbs905lbs1579lbs42.5cmyrl
2102415 8427--matRatio109.0Ratio117.0Ratio118.0--cmmat
Reg# 2102415
BD: January 6, 2018
Frame: 6.3
Owned with RAML Cattle

AAA-W22CEDBWWWYWRADGDMIYHSCDOCCLAWANGLEPAPHPCEMMILKMKHMWMH$EN
BW: 88 lbs
WW: 905 lbs
AAA-W22CWMARBREFAT$M$F$G$B$C
EPD 85-0.011.27-0.0364113435169260 ACC 0.420.360.360.32
RANK% 19515901701525
YW: 1579 lbs
Scrotal: 43 cm
Progeny of Potent Full brother to Potent
S A V
28 | ANGUS 28 | REG.#BORNFRAMEBWWWYWSCROTAL
EPD -14.5891570.331.571.21.29150.460.532.3910.94281351.2-54 ACC 0.360.590.480.420.340.340.510.490.340.270.270.260.250.320.330.380.40 RANK% 959522390320603575806085351295
CACHE
DISCOVERY 2240
MGR TREASURE
0200AN10762 | HIGH POINT CACHE 894 | $35
SJH IMPRESSION OF 6108 1614
GDAR GAME DAY 449
HIGH POINT ELBA 024
HIGH POINT ELBA 843
• Standout individual and a favorite of breeders across the globe who have viewed him in stud
• Combines high growth with breed leading carcass traits
• His muscularity and powerfully constructed body type set him apart from the crowd
19191398 2018/01/296.4yrl78lbs856lbs1405lbs37.4cmyrl
2087914 894--matRatio--Ratio110Ratio113--cmmat
Reg# 2087914
BD: January 29, 2018
Frame: 6.4
AAA-W22CEDBWWWYWRADGDMIYHSCDOCCLAWANGLEPAPHPCEMMILKMKHMWMH$EN
BW: 78 lbs
Progeny at Northern View Angus
WW: 828 lbs
AAA-W22CWMARBREFAT$M$F$G$B$C EPD 760.70.92-0.0016611960180299
ACC 0.420.380.380.36
RANK% 2301035354251010
YW: 1510 lbs
Scrotal: 37 cm
Progeny at Northern View Angus



V A R
29 | ANGUS 29 | REG.#BORNFRAMEBWWWYWSCROTAL
EPD 12.9841570.322.180.81.24-20.550.440.9211.81024700.5-22 ACC 0.370.580.510.440.340.340.460.480.350.290.290.250.260.330.360.400.41 RANK% 908542595202595752545503560403565
COLUMBUS
2240
0200AN10337 | QUAKER HILL COLUMBUS 6V48 | $25
DEER VALLEY RITA 0308
CONNEALY CONFIDENCE 0100
QUAKER HILL BLACKCAP 3N23
QHF BLACKCAP 6E2 OF4V16 4355
• Phenotypically, the most impressive son of Discovery marketed to date
• Impressive combination of BW, WW, SC, DOC, CW, MARB, and REA all ranking in the top 25% of the breed or better



• Was selected for his ability to combine an impressive data set with a balanced, high quality phenotype
• Limited availability in sexed semen
Reg# 2021922
BD: September 1, 2019
Frame: 6.3
BW: 68 lbs
WW: YW:
Scrotal: 38
Dam - QUAKER HILL BLACKCAP 3N23 Columbus
30 | ANGUS 30 |
Progeny
A A R TEN X 7008 S A
V A R DISCOVERY
cm
REG.#BORNFRAMEBWWWYWSCROTAL 18841595 2016/09/016.3yrl68lbs786lbs1360lbs38.0cmyrl 2021922 6V48--matRatio--Ratio--Ratio----cmmat AAA-W22CEDBWWWYWRADGDMIYHSCDOCCLAWANGLEPAPHPCEMMILKMKHMWMH$EN EPD 9-0.9711180.231.260.11.22260.470.392.7412.911264430.1-10 ACC 0.490.750.630.540.400.400.510.490.420.360.370.310.280.380.370.440.46 RANK% 301520356075852515401085352550707035 AAA-W22CWMARBREFAT$M$F$G$B$C EPD 630.820.830.0028810665171310 ACC 0.510.470.450.42 RANK% 1520204031515104
Owned with Quaker Hill Farm and Straightstone Angus LLC
VEZINA
SYDGEN ENHANCE BALDRIDGE SR GOALKEEPER
0200AN10468 | PINE VIEW VEZINA J166 | $30
BALDRIDGE ISABEL E030
CONNEALY MAINSTAY MUSGRAVE ROYAL QUEEN 359
MUSGRAVE ROYAL QUEEN 1317
• Balanced trait sire which is reflected in his top 10% $Maternal, top 10% $Beef and top 3% $C rankings

• Big time EPD spread wtih enhanced foot scores, docility and carcass traits
• Rock solid pedigree combining Baldridge Isabel with his Musgrave Royal Queen dam who was selected as a feature female in the 2020 Musgrave Angus sale

J166matRatio95.0Ratio114Ratio99cmmat
Reg# 20104591
BD: February 25, 2019
Frame: -
Sire - BALDRIDGE SR GOALKEEPER
BW: 66 lbs
WW: 744 lbs
YW: 1168 lbs
Scrotal: 40 cm
31 | ANGUS
REG.#BORNFRAMEBWWWYWSCROTAL 20104591
2020-12-26yrl74lbs744lbs1168lbs39.26cmyrl
AAA-F22CEDBWWWYWRADGDMIYHSCDOCCLAWANGLEPAPHPCEMMILKMKHMWMH$EN EPD 91761380.311.140.81.54310.40.413.9311.51231690.6-25 ACC 0.360.550.480.430.330.330.460.480.360.280.280.250.220.270.300.370.40 RANK% 30451510106025154151595601520453075 AAA-F22CWMARBREFAT$M$F$G$B$C EPD 610.980.940.0218110472176309 ACC 0.410.370.370.35 RANK% 20151065101510103
TOWNSHIP
0200AN10463 | PINE VIEW TOWNSHIP J54 | $30
6095
• A heavily-muscled and fancy-fronted young sire, Township provides great $B, $G, and marbling values



• He has heifer-safe calving ease with weaning and yearling weights that tip the scales.
J54matRatio88.0Ratio90.0Ratio94cmmat AAA-W22CEDBWWWYWRADGDMIYHSCDOCCLAWANGLEPAPHPCEMMILKMKHMWMH$EN
Reg# 20100815
BD: November 21, 2020
Frame: -
BW: 66 lbs
WW: 604 lbs
YW: 1127 lbs
Scrotal: 36 cm
32 | ANGUS G A R ASHLAND
A R HOME TOWN
G
32 | Sire - G A R HOME
DAM - G A R MOMENTUM 57
CHAIR ROCK SURE FIRE
G A R MOMENTUM G A R MOMENTUM 57 G A R PROPHET 2984
TOWN
REG.#BORNFRAMEBWWWYWSCROTAL
20100815 2020/11/21yrl69lbs630lbs1127lbs35.64cmyrl
EPD 15-1.2731260.241.240.50.48150.620.580.817.91031800.5-30 ACC 0.340.530.460.420.340.340.460.490.360.300.300.260.250.270.280.360.38 RANK% 21020255565557565959040903020304085 AAA-W22CWMARBREFAT$M$F$G$B$C EPD 561.770.760.01646102107209317 ACC 0.420.390.390.37 RANK% 30130559015112
OVERHAUL
CONNEALY CONFIDENCE 0100
GAFFNEY GAME CHANGER 371
0200AN10329 | SPRING GROVE OVERHAUL 6133 | $25
R B LADY STANDARD 305-890
MCC DAYBREAK QUAKER HILL BLACKCAP 0A32
QHF BLACKCAP 6E2 OF4V16 4355
• An ideal calving ease bull with added value from carcass traits



• Was selected from a flush of full siblings for his balanced combination of phenotype and data
• His donor dam, Quaker Hill Blackcap 0A32, is the impressive full sister to Quaker Hill Rampage
REG.#BORNFRAMEBWWWYWSCROTAL
18529653 2016/04/255.6yrl77lbs671lbs1321lbs36.0cmyrl
1999190 6133--matRatio--Ratio--Ratio----cmmat
Reg# 1999190
BD: April 25, 2016
Owned with Spring Grove Ranch LLC
AAA-W22CEDBWWWYWRADGDMIYHSCDOCCLAWANGLEPAPHPCEMMILKMKHMWMH$EN
EPD 16-2.656940.220.5100.36160.640.490.785.993118-0.3-1 ACC 0.410.570.490.410.320.320.460.420.360.280.280.270.230.340.350.370.39
RANK% 1265757515958060955540954520959515
AAA-W22CWMARBREFAT$M$F$G$B$C
EPD 340.720.77-0.005588060140240
ACC 0.400.370.370.33
RANK% 854030306560254550
Frame: 5.6
BW:
Dam - QUAKER HILL BLACKCAP 0A32
WW:
YW:
Scrotal: 36 cm
33 | ANGUS 33 |
Full brother to Overhaul
K C F BENNETT SOUTHSIDE MEAD MAGNITUDE MEAD PRIMROSE N198
S A V PRESIDENT 6847
S A V MADAME PRIDE 9962
S A V MADAME PRIDE 3145
• High octane outcross who shattered the EPD barriers at the 2022 SAV sale being the #1 Weaning, #2 Yearling and #1 Carcass weight bull in the entire SAV bull sale offering
• His beautiful dam ranks as the #2 Weaning and #3 Yearling EPD cow in the entire SAV herd!



• His pathfinder grandam , SAV Madame Pride 3145, is a SAV herd favorite with unmatched femininity, fertility, feet and udder quality. She records a progeny IMF ratio of 117 and ribeye ratio of 103 on 26 progeny scanned. She is the third top income producing cow in the SAV herd with 21 daughters retained and 20 progeny highlighting past SAV sales including the $225,000 SAV Anthem and the $200,000 SAV Circuit Breaker
Reg# 20159714
BD: March 4, 2021
Frame: -
Dam - SAV MADAM PRIDE 3145
BW: 85 lbs
WW: 1026 lbs
YW: 1685 lbs
Scrotal: 37 cm
MGS - S A V PRESIDENT 6847
| S A V MAXIMA 1273 | $40
MAXIMA 0200AN10459
34 | ANGUS 34 | REG.#BORNFRAMEBWWWYWSCROTAL 20159714 2021-03-04yrl85lbs1026lbs1690lbs37.1cmyrl
EPD 65.11081880.333.081.30.89300.380.441.0510.2331321.4 ACC 0.380.540.470.420.340.340.450.480.450.290.290.240.230.330.380.41 RANK% 55951149525051030457555102195 AAA-W22CWMARBREFAT$M$F$G$B$C EPD 860.531.15-0.077311161172296 ACC 0.420.380.380.35 RANK% 160212510251010
matRatio110.0cmmat AAA-W22CEDBWWWYWRADGDMIYHSCDOCCLAWANGLEPAPHPCEMMILKMKHMWMH$EN
HIGH COTTON
0200AN10384 | QUAKER HILL HIGH COTTON 9U17 | $25
R B TOUR OF DUTY 177
QUAKER HILL ERICA ELBA 5Y01
• High Cotton is a true heifer-safe calving ease option that brings top 1% calving ease with top 15% BW and an actual BW of 71 lbs
• Calves will take-off and grow as High Cotton boasts WW and YW in the top 4 % or better for the Angus breed



Reg# 2194830
BD: September 16, 2019
Frame:BW: 71 lbs
Sire - K C F BENNETT SUMMATION
WW:YW: -
Scrotal: -
MGS - R B TOUR OF DUTY 177
REG.#BORNFRAMEBWWWYWSCROTAL 19735380 2019-09-16yrl71lbscmyrl 2194830 9U17matRatio95.0cmmat AAA-W22CEDBWWWYWRADGDMIYHSCDOCCLAWANGLEPAPHPCEMMILKMKHMWMH$EN EPD 16-0.8841530.32.220.50.64180.40.423.4712.512311060.5-42 ACC 0.350.540.430.370.300.300.430.390.350.280.280.230.230.290.300.360.40 RANK% 115431595556555152090451520104095 AAA-W22CWMARBREFAT$M$F$G$B$C EPD 720.370.9606711345158272 ACC 0.380.350.340.31 RANK% 58010354010602520
C F BENNETT CONSENT
K
Y75 K C F BENNETT SUMMATION
THOMAS PATRICIA 9705
ELBA
35 | ANGUS 35 |
QUAKER HILL ERICA
5J11
PILLAR
3F EPIC 4631
EXAR MONUMENTAL 6056B
0200AN10375 | EXAR PILLAR 9723B | $30
FWY 7008 OF C085 4029
EXAR DENVER 2002B
WILKS BLACKCAP 4N29
QHF BLACKCAP 6E2 OF4V16 4355
• Deep made, massively thick, good footed and large scrotal individual who was the anchor bull in Express Ranches Grand Champion Pen of 3 bulls at the 2020 Denver National Western Stock Show


• Tremendous marbling EPD backed up by his very high actual 7.72% marbling ultrasound scan
• Dam is a beautifully-patterned, deep-sided, easy-doing donor female with a great udder

19371714 2019/02/016.5yrl74lbs762lbs1437lbs40.5cmyrl
2145903 9723B--matRatio100.0Ratio100.0Ratio100.0--cmmat AAA-W22CEDBWWWYWRADGDMIYHSCDOCCLAWANGLEPAPHPCEMMILKMKHMWMH$EN
Reg# 2145903
BD: February 1, 2019
Frame: 6.5
BW: 74 lbs
WW: 762 lbs
YW: 1437 lbs
Scrotal: 41 cm
36 | ANGUS 36 | REG.#BORNFRAMEBWWWYWSCROTAL
EPD 52.4821430.252.220.51.9150.530.490.2599201250.9-45 ACC 0.400.630.540.460.370.370.490.500.380.310.310.290.270.350.360.410.44 RANK% 658051050955546565553085459031095 AAA-W22CWMARBREFAT$M$F$G$B$C EPD 711.530.560.0333710992201298 ACC 0.460.420.420.40 RANK% 101608095101110 Dam - WILKS BLACKCAP 4N29 CHAMPION PEN
THREE
NWSS
OF
-
Owned with Express Angus Ranches
LAWMAN
SYDGEN ENHANCE S S ENFORCER E813
0200AN10116
| RIVERBEND LAWMAN | $30
S S MISS DAYBREAK K011 3K18
BALDRIDGE COLONEL C251
SPRUCE MTN RITA 8102
BLACK GOLD RITA 527
• Lawman is a calving ease and high carcass merit sire produced from the $115,000 Riverbend Ranch donor Spruce Mountain Rita 8102
• Grandam is the $160,000 famed Express Ranches and Spruce Mountain donor Black Gold Rita 527 who is also the dam of Semex sire Riverbend Upgrade
• Lawman was a Riverbend Ranch sale feature selected by Belvin Angus and Semex as one of the very top combinations of exceptional phenotype and structure with leading edge curve bending performance and carcass data



•
Reg# 20039781
BD: February 4, 2021
Frame: -
3K18
BW: 75 lbs
WW: 762 lbs
YW: 1199 lbs
Scrotal: -
37 | ANGUS 37 |
PGD - S S MISS DAYBREAK K011
MGD - BLACK GOLD RITA 527
EPD 50.2681260.291.210.11.03310.450.521.4211327-0.3 ACC 0.330.470.410.360.290.290.500.470.350.320.320.270.200.270.330.36 RANK% 65303025206590404307055659525909520 AAA-W22CWMARBREFAT$M$F$G$B$C EPD 551.181.11-0.012849996185324 ACC 0.390.360.360.33 RANK% 30103201020242
Owned with Belvin Angus REG.#BORNFRAMEBWWWYWSCROTAL 20039781 02/04/2021yrl75lbs762lbs1199lbscmyrl matRatio25Ratio100.0Ratio100.0cmmat AAA-W22CEDBWWWYWRADGDMIYHSCDOCCLAWANGLEPAPHPCEMMILKMKHMWMH$EN
ELEVATION
BALDRIDGE XPAND X743
BALDRIDGE COLONEL C251
0200AN10742 | MONTANA ELEVATION 7108 | $25
BALDRIDGE ISABEL Y69
DEER VALLEY ALL IN MONTANA BLACKCAP C038
RITA 12H9 OF 9O67 RITO 5M2
• Elevation was produced by an outstanding first calf dam stemming from the breed leading dam for marbling and longtime fixture of the Montana Ranch donor program



• Elevation has impressive muscle expression and base width
• He carries added rib shape and shows tremendous masculinity and traditional breed character
Reg# 2075108
BD: July 1, 2017
Frame: 5.6
BW: 74 lbs
WW: 734 lbs
YW: 1291 lbs
Scrotal: 40
38 | ANGUS 38 |
Sibling to
MONTANA
7116
MGD - RITA 12H9 OF 9O67 RITO 5M2
Elevation -
BLACKCAP
cm REG.#BORNFRAMEBWWWYWSCROTAL 18844589 2017/07/015.6yrl74lbs734lbs1291lbs40.0cmyrl 2075108
AAA-W22CEDBWWWYWRADGDMIYHSCDOCCLAWANGLEPAPHPCEMMILKMKHMWMH$EN EPD 91.3801440.291.880.71.34180.460.392.2511.61236680.2-27 ACC 0.380.570.480.410.330.330.500.460.430.290.290.250.260.320.330.400.43 RANK% 30551010209535255535107560154457080 AAA-W22CWMARBREFAT$M$F$G$B$C EPD 540.860.83-0.003798867155280 ACC 0.410.380.380.35 RANK% 352520301540152515 Owned with Montana Ranch LLC
7108--matRatio96Ratio109Ratio109--cmmat
TENDERLOIN
BASIN PAYWEIGHT 1682
POSS MAVERICK
0200AN10799 | POSS TENDERLOIN | $40
POSS PRIDE 5163
POSS ELEMENT 215
POSS PRIDE 515
POSS PRIDE 379
• High-marbling genetics with more power and mass in a big-outlined body design with eye appeal
• Tenderloin is an attractive, high-marbling, thick-made sire that combines calving ease, performance, carcass, and maternal traits along with a big scrotal and gentle disposition



• Dam is one of the top regarded females in the highly productive Poss Angus herd
Reg# 19778032
BD: February 10, 2020
Frame: 5.2
Sire - POSS MAVERICK
BW: 87 lbs
WW: 725 lbs
YW: 1453 lbs
Scrotal: 40 cm
39 | ANGUS 39 |
PGD - POSS PRIDE 5163
REG.#BORNFRAMEBWWWYWSCROTAL 19778032 2020/02/105.2yrl87lbs744lbs1453lbs39.7cmyrl
AAA-W22CEDBWWWYWRADGDMIYHSCDOCCLAWANGLEPAPHPCEMMILKMKHMWMH$EN EPD 71841500.341.060.40.85230.580.440.4711.79311140.5-46 ACC 0.500.680.610.440.350.350.540.490.360.310.310.250.250.330.350.390.42 RANK% 454544250705530853035554520104095 AAA-W22CWMARBREFAT$M$F$G$B$C EPD 691.130.610.0555611972191304 ACC 0.440.390.380.36 RANK% 101050957031034 Owned with Danny Poss & Peak Dot Ranch
74--matRatio105.0Ratio104.0Ratio112.0cmmat
CASCADE
HOOVER DAM
S S NIAGARA Z29
0200AN10350 | K C F BENNETT CASCADE E380 | $25
JET S S X144
FURTADOS 3117
K C F MISS 3117 C629
K C F MISS 1267 A437
• Calving ease option that is moderate and easy fleshing



• Phenotypically the best built son of Niagara available on the open market
• Impressive combination of low birth, powerful growth and performance as well as strong carcass data
• High quality foot structure illustrated by his top 15% ranking for both claw and foot angle
19153630 2017/09/095.9yrl70lbs660lbs1182lbs36.0cmyrl
2073064 E380--matRatio98Ratio111Ratio109--cmmat
Reg# 19153630
BD: September 9, 2017
Frame: -
AAA-W22CEDBWWWYWRADGDMIYHSCDOCCLAWANGLEPAPHPCEMMILKMKHMWMH$EN
RANK% 11545352545805065151550906510508575
AAA-W22CWMARBREFAT$M$F$G$B$C
EPD 531.061.01-0.0185410380183291
ACC 0.400.360.360.34
RANK% 3510101575154510
BW: 70 lbs
WW: 660 lbs
YW: 1182 lbs
Scrotal: 36 cm
Sire - S S NIAGARA Z29 PGS - HOOVER DAM
40 | ANGUS 40 | REG.#BORNFRAMEBWWWYWSCROTAL
EPD 17-0.7631170.280.970.30.86150.40.41.177.9733660-25 ACC 0.380.550.450.410.310.310.490.460.430.270.270.250.230.290.310.360.39


SITZ DASH 10277 BARSTOW CASH BARSTOW QUEEN W16 WK RETURN WK LASS 1591 VERMILION LASS 0029 41 | ANGUS 41 | REG.#BORNFRAMEBWWWYWSCROTAL 17250190 2012/01/056.5yrl94lbs923lbs1595lbs45.0cmyrl 1727672 4026.5matRatio106Ratio110Ratio11245cmmat AAA-W22CEDBWWWYWRADGDMIYHSCDOCCLAWANGLEPAPHPCEMMILKMKHMWMH$EN EPD 13.8661110.181.350.60.72220.460.590.924.7120190890.4-28 ACC 0.650.940.930.890.420.420.860.860.800.550.570.230.340.810.850.530.45 RANK% 909535459080406030359545959585204080 AAA-W22CWMARBREFAT$M$F$G$B$C EPD 450.790.330.077288550136204 ACC 0.540.480.490.49 RANK% 452580959550405075 SOUTH DAKOTA 0200AN10813 | MOHNEN SOUTH DAKOTA 402 | $30 S A V 004 DENSITY 4336 MOHNEN DENSITY 730 MOHNEN JILT 910 TC ABERDEEN 759 MOHNEN JILT 539 MOHNEN JILT 787 Reg# 1727672 | BD: January 5, 2012 | Frame: 6.5 | BW: 94 lbs | WW: 923 lbs | YW: 1595 lbs | Scrotal: 45 cm CASH
0200AN10821 | KR CASH FLOW | $30 Reg# 17618508 | BD: March 1, 2013 | Frame: 6.5 | BW: 80 lbs | WW: 875 lbs | YW: 1517 lbs | Scrotal: 39 cm REG.#BORNFRAMEBWWWYWSCROTAL 17618508 2013/03/016.5yrl80lbs875lbs1517lbs39.0cmyrl 1788448 3402--matRatio102Ratio107Ratio105--cmmat AAA-W22CEDBWWWYWRADGDMIYHSCDOCCLAWANGLEPAPHPCEMMILKMKHMWMH$EN EPD -13.7651130.221.370.70.42190.380.50.311.121743860.8-25 ACC 0.550.880.840.760.400.400.570.610.410.300.300.260.330.660.680.430.44 RANK% 959535406580307540105530559595201575 AAA-W22CWMARBREFAT$M$F$G$B$C EPD 590.141.13-0.0014410537142228 ACC 0.490.420.430.43 RANK% 20902358515704055 Owned with Davidson Land & Cattle, Peak Dot Ranch,and Krebs Ranch
with Mohnen Angus Farms and Dale Edwards
FLOW
Owned


SYDGEN EXCEED 3223 SYDGEN ENHANCE SYDGEN RITA 2618 CONNEALY CONFIDENCE PLUS MCC SUPERMAMA 8110 MCC ABSOLUTE 6060 REG.#BORNFRAMEBWWWYWSCROTAL 20094111 2020-02-296.1yrl92lbs777lbscmyrl 2169429 042HmatRatio109.0Ratio100.0cmmat AAA-W22CEDBWWWYWRADGDMIYHSCDOCCLAWANGLEPAPHPCEMMILKMKHMWMH$EN EPD 71.1881670.411.651.10.59360.390.566.8513.28341140.7-48 ACC 0.360.520.440.390.350.350.460.420.370.310.310.300.280.330.340.400.43 RANK% 45502119010701158595405510102595 AAA-W22CWMARBREFAT$M$F$G$B$C EPD 751.070.950.0017012178199328 ACC 0.430.390.380.35 RANK% 4101035353521 AMPLIFY 0200AN10391 | SMX AMPLIFY 042H | $30 SYDGEN EXCEED 3223 SYDGEN ENHANCE SYDGEN RITA 2618 CONNEALY CONFIDENCE PLUS MCC SUPERMAMA 8110 MCC ABSOLUTE 6060 Reg# 2169429 | BD: February 29, 2020 | Frame: 6.1 | BW: 92 lbs | WW: 777 lbs | YW: - | Scrotal:ENDORSE 0200AN10110 | SMX ENDORSE 070H | $25 Reg# 2184521 | BD: June 8, 2020 | Frame: - | BW: 84 lbs | WW: - | YW: - | Scrotal:REG.#BORNFRAMEBWWWYWSCROTAL 20094116 2020/06/08yrl84lbscmyrl 2184521Â 070HmatRatio105.0cmmat AAA-W22CEDBWWWYWRADGDMIYHSCDOCCLAWANGLEPAPHPCEMMILKMKHMWMH$EN EPD 13.31021850.362.321-0.14320.420.435.0811.79281080.9-42 ACC 0.350.510.430.380.340.340.440.400.360.300.300.290.270.320.330.390.42 RANK% 90901119510953202595554535101095 AAA-W22CWMARBREFAT$M$F$G$B$C EPD 871.330.830.0118212988217363 ACC 0.410.380.370.34 RANK% 132050101211 42 | ANGUS 42 |
ALPHA
BALDRIDGE TITAN A139
PINE VIEW ALPHA
0200AN10462 | PINE VIEW ALPHA J69 | $25
PINE VIEW BURGESS B066
YON FULL FORCE C398
PINE VIEW RITA G047
PINE VIEW RITA C070
• Alpha stakes his claim as the leader of the pack by being a calving ease bull that ranks in the top 10% or better for WW, YW, RADG, Claw Angle, Foot Angle, Milk, Fat, $M, $G, $B, and $C
• His dam, Pine View Rita G047 has a lineage steeped in highly productive females with ideal udders



20100734 2020/12/22yrl76lbs715lbs1253lbs37.13cmyrl
J69matRatio97.0Ratio109.0Ratio106cmmat
Reg# 20100734
BD: December 22, 2020
Frame: -
AAA-W22CEDBWWWYWRADGDMIYHSCDOCCLAWANGLEPAPHPCEMMILKMKHMWMH$EN
BW: 76 lbs
WW: 715 lbs
YW: 1253 lbs
Scrotal: 37 cm
43 | ANGUS 43 |
REG.#BORNFRAMEBWWWYWSCROTAL
EPD 11-0.3701280.271.330.40.43200.540.471.2912.21325770.4-26 ACC 0.330.550.470.410.310.310.450.480.330.250.250.240.210.270.300.360.39 RANK% 152025203070708045704555501060355075 AAA-W22CWMARBREFAT$M$F$G$B$C EPD 611.130.620.026310875182299 ACC 0.410.370.370.34
PGS
BALDRIDGE
MGS
RANK% 20105065501010510
-
TITAN A139
- YON FULL FORCE C398



44 | ANGUS 44 | PLATTEMERE WEIGH UP K360 E W A 3128 OF 9O67 WEIGH UP RITA 9O67 OF RITA 5M13 OBJ S S HOOVER DAM H27 S S ODYSSEY H71 S S MISS DAYBREAK K07 0200AN10447 | DE-SU EXPEDITION C151 | $25 Reg# 19698673 | BD: May 31, 2019 | Frame: | BW: 72 lbs | WW: - | YW: - | Scrotal: 40 cm EXPEDITION BALDRIDGE XPAND X743 PINE VIEW XPAND E2922 G A R SUNRISE 2922 0200AN10446 | DE-SU RENEGADE C212 | $30 Reg# 8242-PB | BD: October 31, 2019 | Frame: | BW: 74 lbs | WW: - | YW: - | Scrotal: BASIN PAYWEIGHT 1682 POSS MAVERICK POSS PRIDE 5163 RENEGADE PLATTEMERE WEIGH UP K360 E W A 3128 OF 9O67 WEIGH UP RITA 9O67 OF RITA 5M13 OBJ S S HOOVER DAM H27 S S ODYSSEY H71 S S MISS DAYBREAK K07 0200AN10449 | DE-SU QUEST C150 | $25 Reg# 19682222 | BD: May 30, 2019 | Frame: - | BW: 71 lbs | WW: | YW: | Scrotal: 37 cm QUEST AAA-W22CEDBWWWYWRADGDMIYHSCDOCCLAWANGLEPAPHPCEMMILKMKHMWMH$EN EPD 91.5781440.331.321.20.12200.460.412.6410.99261021.2-38 ACC 0.350.510.440.390.310.310.430.420.370.250.250.240.190.300.300.340.37 RANK% 306010104703904535158065455015295 AAA-W22CWMARBREFAT$M$F$G$B$C EPD 800.91-0.0285813673209329 ACC 0.380.350.350.31 RANK% 22010106511011 REG.#BORNFRAMEBWWWYWSCROTAL 19682222 2019-05-30yrl71lbs37.0cmyrl C150--matRatio100.0cmmat AAA-W22CEDBWWWYWRADGDMIYHSCDOCCLAWANGLEPAPHPCEMMILKMKHMWMH$EN EPD 16-2.3731390.331.540.70.28190.460.421.844.71230510.3-16 ACC 0.330.490.430.380.290.290.410.400.350.230.230.210.170.280.290.330.35 RANK% 132010485358550352065951525706050 AAA-W22CWMARBREFAT$M$F$G$B$C EPD 701.10.95-0.0076512080201326 ACC 0.370.330.340.30 RANK% 10101025453411 REG.#BORNFRAMEBWWWYWSCROTAL 19681248 2019-10-31yrl74lbs40.0cmyrl C212--matRatio100.0cmmat AAA-W22CEDBWWWYWRADGDMIYHSCDOCCLAWANGLEPAPHPCEMMILKMKHMWMH$EN EPD 11-1.5661210.320.56-0.11.02320.50.332.6410533680-26 ACC 0.330.490.410.370.300.300.430.400.350.280.280.240.240.310.310.360.38 RANK% 151035305209540350280758510458575 AAA-W22CWMARBREFAT$M$F$G$B$C EPD 651.320.890.0286612587211340 ACC 0.380.360.350.31 RANK% 1531575452211


G A R SUNRISE THOMAS EDISON 6764 THOMAS PRIMROSE 41237 QUAKER HILL RAMPAGE 0A36 ANKONY MISS BLACKCAP 7014 RIVERBEND BLACKCAP C732 REG.#BORNFRAMEBWWWYWSCROTAL 19569272 2019/02/25--yrl81lbs826lbs1300lbs40cmyrl 2141833 9556--matRatio100Ratio100Ratio100--cmmat AAA-W22CEDBWWWYWRADGDMIYHSCDOCCLAWANGLEPAPHPCEMMILKMKHMWMH$EN EPD 101.8861520.321.380.90.89280.50.421.488.3927770.7-27 ACC 0.340.500.430.380.320.320.450.500.370.290.290.260.250.330.340.370.39 RANK% 206533575155010502060904545352580 AAA-W22CWMARBREFAT$M$F$G$B$C EPD 660.771.05-0.0187310567172296 ACC 0.420.390.390.36 RANK% 15354152515151010 HIGH VALUE 0200AN10772 | HART HIGH VALUE 9556 | $25 B/R NEW DAY 454 PA VALOR 201 COR BLACKCAP 6224 Z38 MIDLND A A R TEN X 7008 S A BJ TEN X 4018 2 BAR 5050 NEW DESIGN 2085 Reg # 2141833 | BD: February 25, 2019 | Frame: - | BW: 81 lbs | WW: 776 lbs | YW: 1459 lbs | Scrotal: 40 cm ELECTRIFY 0200AN10364 | NORFOLK ELECTRIFY 29G | $25 Reg# 2080458 | BD: March 11, 2019 | Frame: 6 | BW: - | WW: - | YW: - | Scrotal: 29 cm REG.#BORNFRAMEBWWWYWSCROTAL 19729942 2019/03/116yrl68lbs691lbs1010lbs29.0cmyrl 2080458 29G--matRatio75Ratio--Ratio----cmmat AAA-W22CEDBWWWYWRADGDMIYHSCDOCCLAWANGLEPAPHPCEMMILKMKHMWMH$EN EPD 140.4781380.31.020.40.7790.620.610.3310.11321770.4-23 ACC 0.300.530.420.340.280.280.400.350.290.140.140.140.190.260.270.320.35 RANK% 43510101550706085959530751085355070 AAA-W22CWMARBREFAT$M$F$G$B$C EPD 531.461.13-0.01553103100203316 ACC 0.360.310.320.27 RANK% 3512208015112 45 | ANGUS
Owned with Hart Angus Farm
MONEYBALL
PLATTEMERE WEIGH UP K360
STEVENSON EASY MONEY 70688
0200AN10443 | RB MONEYBALL 080 | $25
DOWN T BLACKBIRD 5646
BASIN PAYWEIGHT 1682
SCHMIDT MISS SKYMERE 613
SCHMIDT MISS SKYMERE 406
• A large spread from birth to yearling, ranking in the top 30% for both CED and BW, top 2% for WW and 1% for YW


• Boasts impressive muscle shape and dimension along with a top 3% ranking for REA
• Moneyball is a square-hipped, structurally-sound, stylish sire!

• He is big-middled and clean-fronted with great carcass performance traits
Reg# 2219888
BD: March 8, 2020
Frame:BW: 70 lbs WW: 843 lbs YW: -
Sire - STEVENSON EASY MONEY 70688
PGS - PLATTEMERE WEIGH UP K360
REG.#BORNFRAMEBWWWYWSCROTAL 19837910 2020-03-08yrl71lbs843lbs--cmyrl 2219888 80matRatio83.0Ratio121.0cmmat AAA-F22CEDBWWWYWRADGDMIYHSCDOCCLAWANGLEPAPHPCEMMILKMKHMWMH$EN EPD 90.2891600.331.850.60.08120.510.352.0714.711201361-50 ACC 0.340.540.460.380.300.300.430.390.340.280.280.260.220.290.300.350.38 RANK% 3030224954595805547025259011095 AAA-F22CWMARBREFAT$M$F$G$B$C EPD 820.351.12-0.0385512850178286 ACC 0.390.340.340.31 RANK% 28024751451015 46 | ANGUS 46 |
Scrotal: -
IMMENSITY
0200AN10478 | WOIRHAYE IMMENSITY 2104 | $30
K C F BENNETT SOUTHSIDE MEAD MAGNITUDE MEAD PRIMROSE N198
BLACKTOP CASH CROP
M A R JEANNE 1845
M A R JEANNE 1631
• #1 performing and leadoff bull at the 60th anniversary 2022 Midland Bull Test
• #1 efficiency bull and #2 ADG bull with an impressive 4.75 lbs/day
• Incredible curve bender and only bull in the Angus breed with his stats of 21 CED & -2.8 BW to a 168 YW



• Pedigree allows for unlimited mating flexibility
Reg# 20051902
BD: January 11, 2021
Frame:BW: 69 lbs
Sire - MEAD MAGNITUDE
WW: 752 lbs
YW: 1339 lbs
Scrotal: 40
PGD - MEAD PRIMROSE N198
47 | ANGUS REG.#BORNFRAMEBWWWYWSCROTAL 20051902 01/11/2021yrl69lbs752lbscmyrl matRatio115cmmat
EPD 21-2.8851680.382.271.41.95250.560.534.018.5361321.3 ACC 0.340.520.450.400.320.320.440.390.340.320.320.220.220.320.370.39 RANK% 1241195142075759585142295 AAA-W22CWMARBREFAT$M$F$G$B$C EPD 800.920.8104312564190289 ACC 0.400.370.360.34 RANK% 230253595220310
cm
AAA-W22CEDBWWWYWRADGDMIYHSCDOCCLAWANGLEPAPHPCEMMILKMKHMWMH$EN
SILVER STAR
0200AN10730 | NORTH CAMP SILVER STAR 5103 | $30
R B ACTIVE DUTY 010
B A LADY 6807 305
WK POW-WOW
MALSONS JILT 13Z
LAFLINS JILT 8302
• Silver Star was a standout in Denver at the 2018 National Western Stock Show
• Progeny are deep-ribbed with added capacity
• Very strong foot structure and soundness
REG.#BORNFRAMEBWWWYWSCROTAL
18162044 2015/02/02--yrl84lbs810lbs1285lbs36cmyrl
2019661 51036.2matRatio--Ratio--Ratio--44cmmat
Reg# 2019661
BD: February 2, 2015
Owned with Guy Lewis Laflin & Hamilton Farms
AAA-F22CEDBWWWYWRADGDMIYHSCDOCCLAWANGLEPAPHPCEMMILKMKHMWMH$EN
EPD 60.750910.240.360.40.68220.490.581.421192021700.6-20 ACC 0.580.870.830.710.390.390.610.600.420.280.290.250.260.510.460.430.44
RANK% 554075755020606030459060554585402560
AAA-F22CWMARBREFAT$M$F$G$B$C
EPD 300.640.560.042428249132213
ACC 0.480.420.430.41
RANK% 804050909060405570
Frame: 6.2
BW: -
Silver Star Progeny at Merit Cattle Co.



WW: -
YW: -
Scrotal: 36 cm
Silver Star Progeny
LCC NEW STANDARD
48 | ANGUS 48 |
PREFERENCE
POSS EASY IMPACT 0119
BALDRIDGE ALTERNATIVE E125
0200AN10426 | PINE VIEW PREFERENCE H119 | $30
BALDRIDGE BLACKBIRD A030
BALDRIDGE WAYLON W34
PINE VIEW RITA B017
PINE VIEW RITA X049
• Preference offers true breed character with exceptional muscle and sound structure with a strong top and sound disposition
• Some EPDs of note include top 1% $C, top 2% WW, CW and $B, top 3% $F, top 4% YW and $G, top 10% hoof angle, docility, marbling and REA
• Phenotypic standout and lead off Lot 1 bull from the 2021 Pine View Sale



Reg# 2197627
BD: January 3, 2020
Frame: -
BW: 86 lbs
WW: 675 lbs
YW: 1305 lbs
Scrotal: 36
49 | ANGUS
Dam - PINE VIEW RITA B017
Sire - BALDRIDGE ALTERNATIVE E125
REG.#BORNFRAMEBWWWYWSCROTAL 19783489 2020-01-03yrl86lbs675lbs1305lbs36cmyrl 2197627
AAA-W22CEDBWWWYWRADGDMIYHSCDOCCLAWANGLEPAPHPCEMMILKMKHMWMH$EN EPD 73.4881490.281.710.40.73290.470.370.4211.411291000.7-39 ACC 0.350.550.470.420.340.340.460.410.360.290.290.270.250.340.340.360.39 RANK% 4590242590706010401030602530152595 AAA-W22CWMARBREFAT$M$F$G$B$C EPD 791.10.94-0.0027411980199332 ACC 0.410.370.370.35 RANK% 2101030253421
cm
H119matRatio109.0Ratio107Ratio105cmmat
UPGRADE
V A R DISCOVERY 2240
DIABLO DELUXE 1104
0200AN10376 | RIVERBEND UPGRADE 8605 | $40
DIABLO ERICA DIANNA 9034
PLATTEMERE WEIGH UP K360
BLACK GOLD RITA 527
GAR/DRMCTR OBJECTIVE 9J86
• Muscular and sound-moving with tremendous body mass all on a solid, sound, well-shaped foot
• Backed by an exceptional dam that was the $160,000 top selling female of the 2019 Spruce Mountain sale with full sisters to Larkspur commanding $100,000 and $50,000



• Top 1% WW, YW, MW, MH, CW, $F & $B. Top 2% RADG and YH. Top 3% $C. Top 5% CEM. Top 10% marbling and $G
REG.#BORNFRAMEBWWWYWSCROTAL
19400049 2018/10/116.2yrl74lbs569lbs1160lbs37cmyrl 2163372 8605--matRatio--Ratio--Ratio----cmmat
Reg# 2163372
BD: October 11, 2018
Frame: 6.2
AAA-W22CEDBWWWYWRADGDMIYHSCDOCCLAWANGLEPAPHPCEMMILKMKHMWMH$EN
BW: 74 lbs
Dam - BLACK GOLD RITA 527
WW: 569 lbs
YW: 1160 lbs
Scrotal: 37 cm
Maternal Sibling - SPRUCE MTN RITA 9523
50 | ANGUS
EPD 52.2961800.342.761.31.1180.430.452.088.314221481.3-57 ACC 0.410.720.640.420.360.360.550.500.390.300.300.290.260.330.340.400.42 RANK% 65751129523045253075855751195 AAA-W22CWMARBREFAT$M$F$G$B$C EPD 851.120.55-0.0074513376208315 ACC 0.450.390.390.36 RANK% 11055258511013
Riverbend
Owned with
Ranch & Spruce Mountain Ranch LLC
RED ANGUS

PAYLOAD
SLGN WIDELOAD 920W
PELTON WIDELOAD 788
0200AR20726 | RAML PAYLOAD 9500 | $40
PELTON MISS JAYLA 05085
HXC CONQUEST 4405P
RAML CHEROKEE MAIDEN 500
WDZ SRV FASHION 1135
• Phenotypic standout! Great body design being stoutfeatured and massive yet has a smooth, attractive look with impeccable foot structure and soundness.

• Will improve the udder quality, foot structure and carcass traits in potential matings


• Backed by cow power stemming from his majestic Conquest dam
REG.#BORNFRAMEBWWWYWSCROTAL
4186622 2019-01-066yrl80lbs691lbs1288lbs42cmyrl
2141837 9500RAML--matRatio--Ratio--Ratio----cmmat
• Checks all the boxes! A must use sire with unlimited mating flexibility
Reg# 2141837
BD: January 6, 2019
Frame: 6.0
RAA-W22CEBWWWYW EPD 12-0.972121 ACC 0.570.690.630.59
RANK% 63652115
RAA-W22MARBCWREAFAT
EPD 0.59400.640.01
0.360.430.410.33
RANK% 2111438
RAA-W22ADGDMIMILKME
0.312.02278
0.590.160.220.10
RANK% 13883771
RAA-W22HPGCEMSTAYYG
BW: 80 lbs
WW: 691 lbs
YW: 1288 lbs
Scrotal: 42 cm
52 | ANGUS 52 | RED ANGUS
EPD
ACC
ACC
EPD 11615-0.05 ACC
Progeny at
0.240.310.330.33 RANK% 57705011 Progeny at Six Mile
Six Mile
Owned with RAML Cattle
MOSSY OAK
RED U-2 RECKONING 149A
RED SIX MILE JOHN WICK 882E
0200AR20729 | SIX MILE MOSSY OAK 175H | $40
RED SIX MILE & CO GLORIA 29A
RUST BULL 31B
RED SIX MILE MISS LARK 225E
RED SIX MILE MISS LARK 300C
• Six Mile Ranch feature sire and sale topper who is one of the most unique individuals ever produced in the Six Mile program, combining superior phenotype and body design with breed leading calving ease and growth EPD’s



• Smooth and balanced attention grabber with herd sire character
REG.#BORNFRAMEBWWWYWSCROTAL
4547373 2020-02-21yrl70lbs888lbs1506lbs36.5cmyrl
2164370 175HSIXMmatRatio86.0Ratio122Ratio122cmmat
Reg# 2164370
BD: February 21, 2020
Frame: -
RAA-W22CEBWWWYW
EPD 15-2.188144
ACC 0.250.470.380.36
RANK% 214411
RAA-W22MARBCWREAFAT
EPD 0.27450.410.03
ACC 0.100.200.150.08
RANK% 842869
Owned with Darren Ippolito & Six Mile Ranch
RAA-W22ADGDMIMILKME
EPD 0.352.563418 ACC 0.360.150.140.08
RANK% 199299
RAA-W22HPGCEMSTAYYG
810170.08 ACC 00.160.110.12
RANK% 9373061
BW: 70 lbs
WW: 893 lbs
YW: -
Scrotal: 37 cm
Full Sibling at Six Mile Sire - RED SIX MILE JOHN WICK 882E
53 | ANGUS 53 | RED ANGUS
EPD
0200AR20728 | DAHLKE ROCKEFELLER 009H | $40
5L ADVANTAGE 3267-221Y
5L BOURNE 117-48A
5L ROXIE 854-117
BIEBER CL ATOMIC C218
DAHLKE MS HILTON 13F ET
DAHLKE MS.HILTON 263C
• Big-outlined, easy-fleshing head turner, in a dark red moderate-framed package with impeccable foot quality
• True curve bender with top 11% BW, top 13% WW & top 14% YW percentile rankings
• Genetic superstar ranking top 1% Pro$, 1% Heifer Pregnancy, 1% Marbling & 1% Gridmaster combining both maternal and carcass quality
REG.#BORNFRAMEBWWWYWSCROTAL
4261367 2020-02-23yrl76lbs720lbs1373lbs39cmyrl
RA4261367 009HBOLDmatcmmat
• Heifer safe, calving ease sire with more growth, mass, and power raised by an exceptional 2-year-old dam



Reg# 4261367
BD: February 23, 2020
Owned with Nathan Jensen
Frame: -
RAA-W22CEBWWWYW EPD 14-4.472116
0.480.500.470.48
RAA-W22ADGDMIMILKME
0.281.623212
BW: 76 lbs
WW: 720 lbs
0.94460.150.03
0.410.420.400.35
YW: 1373 lbs
EPD 188150.18 ACC 0.270.290.360.34 RANK% 1375796 MGD
Scrotal: 39 cm
54 | ANGUS 54 | RED ANGUS
ACC
EPD
RANK% 30111314 ACC
0.480.210.220.14 RANK% 1766592
EPD
ACC
RAA-W22MARBCWREAFAT
DAHLKE
RANK% 124676 RAA-W22HPGCEMSTAYYG
-
MS.HILTON 263C
ROCKEFELLER
DAHLKE ROCKEFELLER 009H
OUTCOME
COLLIER FINAL PRODUCT B389
COLLIER FINISHED PRODUCT
0200AR20727 | DAHLKE OUTCOME 016H | $30
COLLIER AMY B385
ANDRAS FUSION R236
DAHLKE MS. SANDY 271C
DAHLKE TRENDY SANDI 127U
• Breed-leading curve bending sire! Elite calving ease and growth with a fresh outcross pedigree
• Big time herd bull presence who was a favorite all year at Dahlke Red Angus


• Correct-made, long-bodied, and stout-rumped individual in a pleasing dark red package
• “Sleep all night,” heifer-safe sire who excels in all measurable traits and indexes
REG.#BORNFRAMEBWWWYWSCROTAL
4229282 2020-02-28yrl73lbs680lbs1315lbs42cmyrl
2201271 016HARDmatcmmat
Reg# 2201271
BD: February 28, 2020
Frame: -
RAA-W22CEBWWWYW EPD 19-6.057105
0.450.490.480.47
RAA-W22ADGDMIMILKME
0.301.43221
BW: 73 lbs
WW: 680 lbs
EPD
0.42230.240.05
0.380.410.400.34
RAA-W22HPGCEMSTAYYG
EPD 1313170.11 ACC 0.210.250.300.33
YW: 1315 lbs
Scrotal: 42 cm
Sibling at Dahlke Red Angus

55 | ANGUS 55 | RED ANGUS
ACC
EPD
RANK% 226333 ACC
0.470.160.190.15 RANK% 10478439
ACC
RAA-W22MARBCWREAFAT
1812675
RANK% 48512797
RANK%
Sire - COLLIER FINISHED PRODUCT
FURY
0200AR20724 | EGL FURY 8100 | $30
LSF TAKEOVER 9943W
LSF SRR TAKEOVER 5051C
LSF RR SYRINGA U8044 X0331
PIE GET WESTERN 4061
AHL DUCHESS 42W
AHL DUCHESS 106P
• Full-bodied individual with explosive muscle shape and body dimension along with a deep and sweeping rib design
• Dam is one of the strongest donor dams in the Red Angus breed.



• Sound-structured with desirable foot shape and heel depth.
REG.#BORNFRAMEBWWWYWSCROTAL
4048310 2018/01/025.7yrl82lbs713lbs1250lbs38cmyrl
2091768 8100EGL--matRatio100Ratio--Ratio----cmmat
Reg# 2091768
BD: January 2, 2018
Frame: 5.7
RAA-W22CEBWWWYW
EPD 11-3.26287
ACC 0.470.690.650.64
RANK% 75275074
RAA-W22MARBCWREAFAT
EPD 0.47130.200.04
ACC 0.330.410.370.27
RANK% 38793584
RAA-W22ADGDMIMILKME
EPD 0.160.8826-6 ACC 0.640.270.230.15
RANK% 90104412
RAA-W22HPGCEMSTAYYG
118140.05
0.160.300.220.30
RANK% 54306842
BW: 82 lbs
Dam - AHL DUCHESS 42W
WW: -
YW: -
Scrotal: 38 cm
Maternal Brother of Fury
56 | ANGUS 56 | RED ANGUS
EPD
ACC
Owned with Lazy MC Red Angus and Eagle Pass Ranch
RAZOR
ELIMINATOR 9105
DKF ELIMINATOR 15A
0200AR20720 | RED DKF RAZOR 55C | $35
RED DKF MISS POWER 17P
S A V NET WORTH 4200
DKF MISS NET WORTH 21A
DKF MISS POWER UP 95X
• Complete outcross to the Red Angus breed



• Heavy-muscled with an excellent balance and overall eye appeal
• Exceptional performance ranking in the top 14% for WW and YW
• Razor daughters are excelling in production
REG.#BORNFRAMEBWWWYWSCROTAL
3565728 2015/01/276.1yrl76lbs851lbs39.0cmyrl
1877389 55C*DKF--matRatio--Ratio--Ratio----cmmat
Reg# 1877389
BD: January 27, 2015
Frame: 6.1
RAA-W22CEBWWWYW
EPD 81.575122 ACC 0.690.880.840.82
RANK% 93921414
RAA-W22MARBCWREAFAT
EPD 0.1846-0.050.02
ACC 0.520.610.550.41
RAA-W22ADGDMIMILKME
0.291.922711
0.820.270.630.31
RANK% 17834086
RAA-W22HPGCEMSTAYYG
0.320.590.380.43
BW: 69 lbs
WW: 851 lbs
YW: -
Scrotal: 39 cm
Progeny of Razor
S A V
57 | ANGUS 57 | RED ANGUS
EPD
ACC
EPD 144160.23 ACC
RANK% 9068060 RANK%
18924696
Progeny of Razor
CUSTOM MADE
0200AR20722 | RED SIX MILE CUSTOM MADE 505C | $35
RED U-2 RECON 192Y
RED U-2 RECKONING 149A
RED U-2 ANEXA 271Y
RED BASIN EXT 45T5
RED SIX MILE LASSIE 207Z
RED SIX MILE LASSIE 377P
• Phenotypically one of the outstandingly built sires in the Red Angus Breed



• An attractive, highly maternal sire who ranks in the top 28% for Milk EPD
• Custom Made daughters are making tremendous females with flawless udder and teat structure
REG.#BORNFRAMEBWWWYWSCROTAL
3607375 2015/04/016.3yrl84lbs893lbs1417lbs39.0cmyrl
1858482 505CSIXM--matRatio--Ratio--Ratio----cmmat
Reg# 1858482
BD: April 1, 2015
Frame: 6.3
RAA-W22CEBWWWYW
EPD 80.25682
ACC 0.560.850.810.78
RANK% 91817081
RAA-W22MARBCWREAFAT EPD 0.49170.180.02 ACC 0.310.490.440.31
RANK% 35683850
Owned with Six Mile Angus
RAA-W22ADGDMIMILKME
0.161.2128-6
0.780.280.600.31
RANK% 88272812
RAA-W22HPGCEMSTAYYG
0.320.510.360.35
RANK% 83521028
BW: 81 lbs
Dam - RED SIX MILE LASSIE 207Z
WW: 1106 lbs
YW: -
Scrotal: 39 cm
Progeny of Custom Made
58 | ANGUS 58 | RED ANGUS
EPD
ACC
EPD
ACC
97190.02
SIMMENTAL

EPIC
0200SM30725 | WS EPIC E152 | $40
WS ALL-AROUND Z35
WS ALL ABOARD B80
WS LITTLE SISTER W37
GW RED COAT 099TS
WS MAJESTIC Z133
WS MOTHER LODE W21
• Homozygous polled
• One of the most popular Red Simmental sires in the breed


• First progeny at Wheatland Cattle were born easy, with low birthweights, and have performed exceptional at weaning
REG.#BORNFRAMEBWWWYWSCROTAL
3254258 2017-01-096.5yrl93lbs777lbs1363lbs39cmyrl
1237011 SMX152E--matRatio100Ratio100Ratio100--cmmat
• Stout-featured, with unmatched body of depth, and breed leading EPDs from low birthweight to high performance

Reg# 1237011
BD: January 9, 2017
Frame: 6.5
CSA-W22CEBWWWYW
13.2-1.194.1149.4
0.760.880.840.81
RANK% 10231
CSA-W22CWTMARBREAFAT
390.070.9-0.099
0.610.540.550.49
Owned with Wheatland Cattle Co.
BW: 93 lbs
Daughter at McIntosh Livestock
WW: 777 lbs
YW: 1363 lbs
Scrotal: 39 cm
Son at Wheatland Cattle Co.
60 | SIMMENTAL 60 |
EPD
ACC
CSA-W22MCEMWWTMILKSTAY EPD
ACC
4.372.325.210.4
0.520.600.480.41 RANK% 502565100
EPD
ACC
CSA-W22APITPI EPD 131.4890.61 ACC RANK%
RANK% 10154570
TRUE NORTH
HTF/SVF DURACELL T52
GSC GCCO DEW NORTH 102C
WELSH’S SCARLET 161Z
W/C RELENTLESS 32C
COX’S JOYS PRINCESS 711E
GCC JOYS ELEGANCE 199Y
• Homozygous for both Polled and Black Purebred!



• Unmistakable look and presence combined with being soft-sided, great-haired, square-hipped and big- topped
• Exciting outcross sire with impeccable structure being easy going and fluid on the move
REG.#BORNFRAMEBWWWYWSCROTAL
3640090 2019-02-05--yrl76lbs758lbs--cmyrl
1361732 FGN71G--matRatio--Ratio--Ratio----cmmat CSA-W22CEBWWWYW
• Tremendous cow family with dam and granddam having great udders and feet to go with their many championship titles
Reg# 1361732
BD: February 5, 2019
Frame: -
Dam - COX’S JOYS PRINCESS 711E
BW: 76 lbs
WW: 758 lbs
YW: -
Scrotal: -
61 | SIMMENTAL 61 |
0200SM30344 | LLW CARD TRUE NORTH G71 | $55
Owned with Wheatland Cattle Co. & Lucas Wisnefski
EPD
ACC
RANK%
CSA-W22MCEMWWTMILKSTAY EPD 6.558.121.412.5 ACC 0.310.320.190.34 RANK% 20909090 CSA-W22CWTMARBREAFAT EPD 12.20.020.93-0.085 ACC
RANK%
CSA-W22APITPI EPD 120.274.66 ACC RANK%
13.7-0.573.396.6
0.580.660.570.54
536585
0.440.400.440.35
100253590
Daughter at Diamond M Cattle Company
ASSET
0200SM30730 | ERIXON ASSET | $30
KWA LAW MAKER 59C DOUBLE BAR D LIBERATOR 412E
DOUBLE BAR D GALAXY 101X
KUNTZ SHERIFF 8A
ERIXON LADY 15D
ERIXON LADY 75B
• Homozygous polled
• Exciting new sire with a commanding presence who will be on the “must use list”
• Balanced multi-trait excellence in an eye-appealing package with impressive body dimension, capacity and soundness
• Checks all the boxes from calving ease and low birthweight to yearling, docility, marbling, ribeye, API and TI
Reg# 1348367
BD: January 25, 2019
CSA-W22CEBWWWYW
REG.#BORNFRAMEBWWWYWSCROTAL 2021-01-17yrl89lbs733lbs1411lbscmyrl CSA-W22APITPI EPD 132.2578.14 ACC RANK%
Frame: -
0.230.350.310.33
BW: 89 lbs
WW: 733 lbs
YW: 1411 lbs
Owned with McIntosh Livestock Sire - DOUBLE BAR D LIBERATOR 412E CSA-W22MCEMWWTMILKSTAY EPD 5.76928.218.8 ACC 0.170.200.150.12 RANK% 30404515 CSA-W22CWTMARBREAFAT EPD 45.8-0.020.97-0.104 ACC 0.210.120.170.10 RANK% 2402560



62 | SIMMENTAL 62 |
MGD - ERIXON LADY 75B
1348367 matcmmat
EPD 11.21.581.6138.3 ACC
Scrotal:RANK% 1515305
STATE OF WAR
0200SM30722 | HART STATE OF WAR 056C | $35
FBFS WARSAW 068W
WELSH’S WARSAW 312Z
WELSHS ROSIE 102W
SKORS BLACK ENTICER 287Y HART MISS 102A
HART MISS X534
• Homozygous Polled, Homozygous Black
• Progeny are highly sought after and have topped sales across western Canada



• Amazing EPD profile excelling in CE and low BW to top ranking performance
• Outcross pedigree with unmatched proven curve bender EPDs
REG.#BORNFRAMEBWWWYWSCROTAL
2975543 21/02/20156.2yrl74lbs900lbs1424lbs39.0cmyrl
1180101 MRL056C--matRatio--Ratio--Ratio----cmmat
Reg# 1180101
BD: February 21, 2015
Frame: 6.2
CSA-W22CEBWWWYW
0.780.900.860.84
RANK% 12155
BW: 74 lbs
Progeny at Erixon Simmentals
WW: 900 lbs
YW: 1424 lbs
Scrotal: 39 cm
1046090
Progeny at Hart Simmentals
63 | SIMMENTAL 63 |
EPD
ACC
18.4-1.286.9138.3
CSA-W22MCEMWWTMILKSTAY EPD 10.576.633.120 ACC 0.550.650.550.41 RANK% 110305
EPD
ACC
CSA-W22APITPI EPD 159.0689.64 ACC RANK%
CSA-W22CWTMARBREAFAT
39.50.160.84-0.085
0.600.570.640.44 RANK%
AFFINITY
WS PILGRIM H182U
CCLT ALLIANCE 91C
0200SM30727 | WHEATLAND AFFINITY 8196F | $30
BROOKS SHINIA 1A
GOLDEN OPPORTUNITYHR R851
WHEATLAND LADY 913W
WHEATLAND LADY 751 T
• One of the most sought after red sons of the popular black sire CCLT Alliance at the Wheatland 2019 Bull Sale



• Exceptional body build with an attractive look
• Dam has impeccable udder quality and maternal ability
• Homozygous Polled
REG.#BORNFRAMEBWWWYWSCROTAL
3625286 2018/04/166.4yrl84lbs869lbs1440lbs40.0cmyrl
1252370 LER8196F--matRatio--Ratio--Ratio----cmmat
Reg# 1252370
BD: April 16, 2018
Frame: 6.4
CSA-W22CEBWWWYW
0.630.760.690.66
RANK% 2010100100
Owned with Bonchuck Farms
BW: 83 lbs
Sire - CCLT ALLIANCE 91C
WW: 869 lbs
YW: 1543 lbs
Scrotal: 40 cm
Progeny at Indian River Cattle Co.
64 | SIMMENTAL 64 |
EPD
ACC
10.4161.475.2
CSA-W22MCEMWWTMILKSTAY EPD 3.556.425.712.4 ACC 0.320.380.220.33 RANK% 60956095
EPD
ACC
RANK%
CSA-W22APITPI EPD 110.6866.63 ACC RANK%
CSA-W22CWTMARBREAFAT
130.080.63-0.115
0.490.410.490.36
100159540
DIMENSION
MR NLC UPGRADE U8676
MR TR HAMMER 308A ET
0200SM30726 | CKCC LD DIMENSION 8965 | $35
SVF/HS EXPECTING A DREAM
GKS RE-HAB
WF FOREVER LADY Z165
WF U165
• Homozygous Black, Homozygous Polled
• Outstanding phenotype sire out of one of the top donor cows in the USA

• Sound, structured and soft-sided with an appealing look and a great foot
REG.#BORNFRAMEBWWWYWSCROTAL
3507444 2018/03/27--yrl85lbs726lbs1259lbs40cmyrl
BPTG1304903 FGN8964F--matRatio--Ratio--Ratio----cmmat CSA-W22CEBWWWYW
8.83.998.6154.8
Owned with Wheatland Cattle Co.
• First sons were featured and sought after in the 2022 Bull sale season with high sellers in the Wheatland Cattle Co. and McIntosh Livestock bull sales


Reg# BPTG1304903
BD: March 27, 2018
Frame: -
BW: 85 lbs
Supreme Champion Pen of Bulls at Canadian Western Agribition 2021 sired by Dimension
WW: 726 lbs
YW: 1259 lbs
Scrotal: 40 cm
Progeny at Wheatland Cattle Co.
65 | SIMMENTAL 65 |
EPD
ACC
RANK%
CSA-W22MCEMWWTMILKSTAY EPD 366.417.111.8 ACC 0.300.350.230.36 RANK% 655010095
EPD
ACC
RANK%
CSA-W22APITPI EPD 112.2781.85 ACC RANK%
0.520.610.590.57
355511
CSA-W22CWTMARBREAFAT
46.7-0.11.1-0.107
0.460.410.450.38
270450
BOUNTY HUNTER
0200SM30721 | WLB BOUNTY HUNTER 365C | $35
LFE RANCHER 396U
LFE BOUNTY 3118Z
LFE BS KEEPSAKE 158S
LFE THE DARK NIGHT 350U
LFE BS MARY 26A
LFE BS MARY 25U
• Homozygous Polled, Homozygous Black Purebred
• Proven moderate calving ease sire with leading growth and marbling



• He ranks at the top of the breed for CWT and 10% for MARB
REG.#BORNFRAMEBWWWYWSCROTAL
3165786 2015-01-036.4yrl93lbs719lbs1394lbs39cmyrl
1142666 WLB365C--matRatio104Ratio97Ratio102--cmmat
• Transmits his exceptional body depth and easy fleshing ability to both his sons and daughters in production
Reg# 1142666
BD: January 3, 2015
Frame: 6.4
CSA-W22CEBWWWYW
11.6382.5134
ACC 0.730.860.810.80
RANK% 15402510
CSA-W22CWTMARBREAFAT
50.10.120.85-0.073 ACC 0.560.510.480.42
RANK% 1106095
0.530.640.550.42 RANK% 4010010030
BW: 93 lbs
Progeny at 3WLB Livestock
WW: 719 lbs
YW: 1394 lbs
Scrotal: 39 cm
66 | SIMMENTAL
66 |
Progeny at McIntosh Livestock
EPD
EPD
ACC
CSA-W22MCEMWWTMILKSTAY
4.753.111.817.3
EPD
CSA-W22APITPI EPD
ACC RANK%
133.5777.86
2019/01/25--yrl--cmyrl 08G--matRatio--Ratio--Ratio----cmmat
HOOKS SHEAR FORCE 38K HOOK’S BEACON 56B
ZAFIRAH 41Z


DAYBREAK EAGLE PASS DAYBREAK 0022 ET EGL MISS NEW DESIGN 1171
17.9-2.471.6114
0.460.480.500.51
5157060
10.85923.212.8
0.300.330.260.36 RANK% 4605075
55.80.931.350.019
0.460.450.440.41
32199
2019/01/205.7yrl592lbs1232lbs38.0cmyrl
FGN86G--matRatio--Ratio--Ratio----cmmat CSA-W22CEBWWWYW
17.1-2.272.3111.8
170.594.7
67 | SIMMENTAL
MCC
REG.#BORNFRAMEBWWWYWSCROTAL 3655891
ASA-W22CEBWWWYW EPD
ACC
RANK%
EPD
ACC
ASA-W22CWTMARBREAFAT EPD
ACC
RANK%
EPD
ACC RANK%
REG.#BORNFRAMEBWWWYWSCROTAL 3655937
1322284
EPD
ACC 0.470.500.520.53 RANK% 117050 CSA-W22MCEMWWTMILKSTAY EPD 9.366.930.715.7 ACC 0.310.350.270.34 RANK% 3503555 CSA-W22CWTMARBREAFAT EPD 37.30.460.89-0.045 ACC 0.470.460.460.41 RANK% 15145100 CSA-W22APITPI EPD 148.983.95 ACC RANK% GREAT WESTERN 67 | 67 | SIMANGUS 0200SM30345 | EGL GREAT WESTERN 86G | $20 SYDGEN C C & 7 T C A VISIONARY 158 T C A TREASURE 0699 601 MR NLC UPGRADE U8676 TJ 22X MS MISS 306R Reg# 1322284 | BD: January 20, 2019 | Frame: 5.7 | BW: - | WW: 592 lbs | YW: 1232 lbs | Scrotal: 38 cm 0200SM30346 | EGL GROWLER 08G | $25 Reg# 3655891 | BD: January 25, 2019 | Frame: - | BW: - | WW: - | YW: - | Scrotal: -
HOOKS
ASA-W22MCEMWWTMILKSTAY
ASA-W22APITPI
GROWLER
SENSATION
MACKENZIE’S CANE 122Y
BIG HILLS CANE 62B
0200SM30728 | GRINALTA’S HP SENSATION FF909D | $35
EAGLE-RIDGE ZABIA
GRINALTA’S HP KING 126S GRINALTA’S FRITA-PPFF109W
GRINALTA’S BERTA PFF109T
• Homozygous Polled Full Fleckvieh

• Sensation offers a fresh, yet time tested pedigree to our Full Fleckvieh Simmental lineup with the added feature of being Homozygous Polled.


• Solid built sire possessing great depth of body with tremendous muscle expression combined with soundness of movement and a well shaped foot
REG.#BORNFRAMEBWWWYWSCROTAL
3696167 2016/04/176.4yrl68lbs830lbs1466lbs45.5cmyrl
P1242762 IE909D--matRatio--Ratio--Ratio----cmmat
• One of the most complete Homozygous Polled Full Fleckvieh sires we’ve ever come across
Reg# P1242762
BD: April 17, 2016
Frame: 6.4
Progeny of Sensation
BW: 85 lbs
WW: 863 lbs
YW: 1466 lbs
Scrotal: 46 cm
Sibling to Sensation
EPD 4.2573.6110.7 ACC 0.510.640.490.50 RANK% 85756555 CSA-W22MCEMWWTMILKSTAY EPD 1.775.438.69.4 ACC 0.230.280.170.27 RANK% 801510100 CSA-W22CWTMARBREAFAT EPD 23.2-0.181.17-0.145 ACC 0.420.300.400.26 RANK%
CSA-W22APITPI EPD 84.7965.15 ACC RANK% 68 | SIMMENTAL 68 | FLECKVIEH
CSA-W22CEBWWWYW
709523
POL EDDY
SIBELLE DIRTY HARRY 25Z
FGAF FRENCH ATTACK 010C
CSA-W22CEBWWWYW EPD 1.96.280.6104.5
0.560.690.580.57
RANK% 95903070
CSA-W22CWTMARBREAFAT
13-0.050.93-0.163
0.430.350.420.29
0200SM30341 | FSMB POL EDDY 3E | $25
VIRGINIAS JANE WEST
CHAMPS BRAVO
FSMB MISS BRAVO 8A
FSMB MISS FRANCHESCA 14W
• Eddy balanced the power and performance from his Dirty Harry sire line with the maternal and calving prowess of Bravo on his dam side


• He is well-pigmented, well-muscled and carries dark black hooves.
• Balances EPDs to go with strong phenotype of high growth and strong maternal
Reg# 1226358
BD: January 4, 2017
Frame: 5.8
Sire - FGAF FRENCH ATTACK 010C

BW: 94 lbs
WW: 1050 lbs
YW:
Scrotal: 38 cm
Sibling of Pol Eddy
ACC
CSA-W22MCEMWWTMILKSTAY EPD -2.673.533.213.2 ACC 0.300.290.150.32 RANK% 100202585
EPD
ACC
RANK%
CSA-W22APITPI EPD 94.1469.07 ACC RANK% 69 | SIMMENTAL 69 | FLECKVIEH
10050351
BANK ROLL
VIRGINIA WALKER 97W
SIBELLE
DIRTY HARRY 25Z
0200SM30335 | PHS BANK ROLL 345B | $25
SIBELLE GOLDA
BLI WARLORD 915W
PHS YUMA
FGAF PRECIOUS THING 402T
• Polled Fleckvieh Fullblood


• Bank Roll was the featured $16,000 polled son of Dirty Harry

• His sire, Dirty Hairy, sold for $35,000 at the epic Prospect Hill Dispersal
• Moderate-framed with exceptional shape and performance at an early age
REG.#BORNFRAMEBWWWYWSCROTAL
3047163 2014/03/026.3yrl89lbs861lbs41.0cmyrl
802872 AP345B--matRatio106Ratio99Ratio----cmmat
Reg# 802872
BD: February 3, 2014
Frame: 6.3
CSA-W22CEBWWWYW
5.95.174.7109
0.600.770.690.64
70806060
BW: 89 lbs
Dam - PHS YUMA
WW: 861 lbs
YW:
Scrotal: 41 cm
Progeny of Bank Roll
EPD
ACC
RANK%
CSA-W22MCEMWWTMILKSTAY EPD 2.973.836.419.8 ACC 0.420.560.500.39 RANK% 70202010 CSA-W22CWTMARBREAFAT EPD
ACC
RANK%
CSA-W22APITPI EPD 102.9163.35 ACC RANK% 70 | SIMMENTAL 70 | FLECKVIEH
31-0.251.08-0.132
0.520.440.500.36
351001015
ROCKET
GRINALTA’S GRIDIRON 403J
DFM MARCUS 14M
CSA-W22CEBWWWYW
EPD 4.25.276.1104.5 ACC 0.690.830.770.78
RANK% 85805070
CSA-W22CWTMARBREAFAT
0200SM30326 | LRX HP ROCKET 23Y | $25
DFM KATHLEEN 41K
GSEVEN POL ROCKET 12P
LRX MS ROCKET 3W
LRX MARCY 40T
• Homozygous Polled Fleckvieh Fullblood

• Still favoured as one of the top homozygous polled
• Calving ease fullblood sires with high quality progeny


• Pedigree contains Iroc Rocket
Reg# 747235
BD: January 7, 2011
Frame: 6.7
Progeny at Robb Farms
BW: 94 lbs
WW: 879 lbs
YW: 1506 lbs
Scrotal: 36 cm
Progeny at Robb Farms
CSA-W22MCEMWWTMILKSTAY EPD -0.569.831.711.7 ACC 0.500.630.560.43 RANK% 95353095
EPD
ACC
RANK%
CSA-W22APITPI EPD 86.5164.3 ACC RANK% 71 | SIMMENTAL 71 | FLECKVIEH
27-0.21.11-0.143
0.590.480.510.37
5010045
HEXTOR
CONGOSIM HEXVAS BAR 5 FF HEXAGON 412Y
0200SM30336 | BAR 5 HEXTOR 1223C | $25
RAAP N SKRAAP MARDA
DORA LEE ECLIPSE FF9R
DORA LEE’S DANIELLA FF8W
DORA LEE DARBY FF8N
• Polled Fleckvieh Fullblood
• Sired by Hexagon who is an outcross bull highly noted for his outstanding profile and colour



• Hextor is a low BW sire ranking in the top 15% of the breed
• Highly maternal with a top 10% ranking for Milk EPD
REG.#BORNFRAMEBWWWYWSCROTAL
3172322 2015-03-166.1yrl89lbs713lbs40cmyrl
1155074 CO1223C--matRatio119Ratio--Ratio----cmmat
Reg# 1155074
BD: March 16, 2015
Frame: 6.1
CSA-W22CEBWWWYW
0.35.679.3108.8
ACC 0.530.660.550.52
CSA-W22CWTMARBREAFAT
EPD 25.20.140.79-0.14 ACC 0.390.360.420.33
CSA-W22MCEMWWTMILKSTAY
-2.478.839.115.5
BW: 89 lbs
Progeny of Hextor
WW: 713 lbs
EPD
108.1673.69
YW:
Scrotal: 40 cm
Progeny of Hextor
EPD
EPD
RANK% 100854060 ACC
0.280.310.190.28
RANK% 10051055
RANK% 6057510 ACC RANK% 72 | SIMMENTAL 72 | FLECKVIEH
CSA-W22APITPI
ULTRA INDEPENDENCE
0200SM30810 | ULTRA INDEPENDENCE 26J | $30
STARWEST POL BLUEPRINT
SUNNY VALLEY FREEDOM 22F
SUNNY VALLEY TRINITY 53Z
ANCHOR D RAPTOR 392C
WJS ERIKA 748E
PHS YOUR CHOICE
• Polled Fullblood Fleckvieh



• Independence is a sure-footed, dark-pigmented, solid all-around sire that we have been waiting for
• Progeny will take off and grow, while proving great returns on the rail with top 4% MARB and top 3% Fat
Reg# PT1354128
BD: January 7, 2021
Frame:
CSA-W22CEBWWWYW
BW: 88 lbs
Dam - WJS ERIKA 748E
WW: 753 lbs
YW: -
Scrotal:
Paternal Sibling sold for $32,000
EPD
74.695144 ACC 0.380.410.380.38
CSA-W22MCEMWWTMILKSTAY EPD 5.189.942.411.6 ACC 0.190.210.120.26 RANK% 351295
EPD 39.90.170.88-0.147 ACC
RANK% 104503 CSA-W22APITPI EPD 120.5187.54 ACC RANK% 73 | SIMMENTAL 73 | FLECKVIEH
RANK% 557032
CSA-W22CWTMARBREAFAT
0.330.290.310.26
CHAROLAIS

TRIUMPH
FC MARBLER 841 P
SCR TUFFY 0119
SCR MISS KING MICKY 7055
JCH MR BULL DOZER P146
SCR MS BABY DOLL 7140
SCR MISS ROYALTY 9302
• Homozygous Polled
• One of the most impressive Charolais sires one will come across. His overall body capacity and muscle mass is extremely impressive, along with impeccable structure and foot quality on this must use sire



• Excellent performance figures begin top 1% WW and top 1 % YW along with a tremendous top 4% CWT ranking
M816393 2012/02/227yrl100lbs647lbs1422lbs46cmyrl
PMC355788 SCX2135Z--matRatio--Ratio--Ratio----cmmat
BD: February 22, 2012
Frame: 7.0
0.610.850.680.630.53
RANK% 75651195
BW: 100 lbs
WW: 647 lbs
YW: 1422 lbs
Scrotal: 46 cm
75 | CHAROLAIS
by Serhienko Char, Hunter Char, Semex & Footprint Farms 75 | CHAROLAIS REG.#BORNFRAMEBWWWYWSCROTAL
Owned
EPD
ACC
CCA-W22CEBWWWYWMILK
3.61.56512715
CCA-W22CWTMARBREAFAT EPD 29-0.270.491.506 ACC 0.220.270.270.36 RANK% 4903595
0200CH50318 | SCR TRIUMPH 2135 | $30
Reg# PMC355788
Progeny of Triumph - SCX JEHU 233E
Progeny of Triumph
TRIED AND TRUE
LT RIO BRAVO 3181 LT RUSHMORE 8060 LT BRENDA’S EASE 3055 LT BLUE VALUE 7903
CCC SWEETHEART 6644 P
WC CCC SWEETHEART 1140 P
• Proven top level calving ease genetics with performance
• Stout-made sire with high capacity body mass set on a sound and solid foot structure

• Dam is a powerful Blue Value daughter, displaying incredible consistency in her production, who has moved into the Cody Cattle Co. donor program


EM944451 2018/09/02yrl70lbs863lbs--cmyrl
MC801637 ELH8507FmatRatio101.0Ratio110.0cmmat
Reg# MC801637
BD: September 2, 2018
Frame: -
- WC CCC SWEETHEART 1140
BW: 70 lbs
12.7-1.1468022
0.400.690.500.340.22 RANK% 525457050
WW: 863 lbs
YW: -
Scrotal: -
76 | CHAROLAIS 76 | CHAROLAIS REG.#BORNFRAMEBWWWYWSCROTAL
EPD
ACC
CCA-W22CWTMARBREAFAT EPD 130.420.331.658 ACC
CCA-W22CEBWWWYWMILK
0.170.160.180.24 RANK% 753585100
| CCC TRIED AND TRUE 8507 P | $40
ET WC
ET
0200CH50717
MGD
Progeny at Harvie Ranching
Owned with Cody Cattle Co and Harvie Ranching
WHEATON
LT RIO BRAVO 3181 P
LT RUSHMORE 8060 PLD
0200CH50719 | SPARROWS WHEATON 101J | $45
LT BRENDA’S EASE 3055PLD
WINN MANS SKAGGS 663X
SPARROWS SPLENDOR 135G
SPARROWS SPENDOR 135A
• The total package! Wheaton is a standout in terms of body volume and internal dimension with strong performance, softness and moderation
• Featured Lot 1 bull from the 2022 CK Sparrow Farms sale


• Dam is a great-uddered, good-haired, strong-footed Winn Mans Skaggs daughter
2021-01-08yrl83lbs815lbs1326lbs44cmyrl
PMC822805 matRatio105Ratio103Ratio104cmmat
Reg# 822805
BD: January 8, 2021
Frame:BW:WW: -
YW: -
Sire - LT RUSHMORE 8060 PLD
Scrotal: -

77 | CHAROLAIS
77 | CHAROLAIS
PGS - LT RIO BRAVO 3181 P
REG.#BORNFRAMEBWWWYWSCROTAL
CCA-W22CEBWWWYWMILK EPD 14.9-3.4428824 ACC 0.230.370.260.230.12 RANK% 210655030 CCA-W22CWTMARBREAFAT EPD 140.560.31.582 ACC 0.100.060.080.10 RANK% 702590100
BADGE
217CH4575 | LT BADGE 9184 | $65
PLEASANT DAWN MVP 316Y
TURNBULL’S ELITE 322E
CTP MISS ELICIT 322Z
SPARROWS KINGSTON 139Y
CEDARLEA UTAH 53D
CEDARLEA UTAH 51Y
• Well-balanced sire with a bold future. His first sons in the LT Ranch 2022 sale were the talk of the industry



• His sons excel at multiple traits, including superior performance, disposition, scrotal and feet
• His daughters are feminine with added body
REG.#BORNFRAMEBWWWYWSCROTAL
M927067 03/08/2019yrl86lbs739lbs1325lbscmyrl matRatio100.0Ratio98.0Ratio102.0cmmat CCA-W22CEBWWWYWMILK
Reg# M792075
BD: March 08, 2019
Frame: 6.7
Son - LT GOVERNOR 1560 PLD
BW: 89 lbs
WW: 739 lbs
YW: 1325 lbs
Scrotal: 39 cm
Son - LT JUSTIFIED 1528
78 | CHAROLAIS 78 | CHAROLAIS
EPD
ACC
CCA-W22CWTMARBREAFAT EPD 170.230.441.633 ACC 0.160.170.190.24 RANK% 555050100
10.1-2.9529517
0.330.580.370.310.20 RANK% 1510203090
DEL REY
• Homozygous Polled
• Top level proven calving ease and low birth weight sire with added marbling



• Hard to beat rankings with top 1% Calving Ease, Top 1% BW and top 2% Marbling
• Well-built and smooth-made with added muscle shape
REG.#BORNFRAMEBWWWYWSCROTAL
M880361 2016/03/046yrl76lbs759lbs1120lbs38cmyrl
PMC739572 FPF6161D--matRatio--Ratio--Ratio----cmmat
BD: March 4, 2016
Frame: 6.0
CCA-W22CEBWWWYWMILK
EPD 20-7.7436826
ACC 0.600.840.640.570.30
RANK% 11659515
CCA-W22CWTMARBREAFAT EPD 21.490.062.801 ACC 0.210.250.260.34
RANK% 1002100100
BW: 76 lbs
Progeny at Footprint Farms
WW: 759 lbs
YW: 1120 lbs
Scrotal: 38 cm
Progeny at Footprint Farms
79 | CHAROLAIS 79 | CHAROLAIS
0200CH50320 | LT DEL REY 6161 P | $25
PLD
PLD
PLD
P
ET
LT LONG DISTANCE 9001
LT LONGNECK 3031
LT WILLOW 1265
LT BLUEGRASS 4017
LT MAXINE 7908
LT DUCHESS OF MAC 7076 P
Reg# PMC739572
Owned with Footprint Farms
YELLOWSTONE
0200CH50716
EM946176 2019-12-226.6yrl86lbs750lbs1462lbs43cmyrl
MC817410 939GmatRatio107.0Ratio99Ratio100cmmat
CCA-W22CEBWWWYWMILK
EPD 10.6-3499624
ACC PE0.150.130.100.03
RANK% 1510353030
CCA-W22CWTMARBREAFAT
BHD PERSEUS B65 P
DC/CRJ TANK E108 P
CRJ MS ZYLEN C1587
M6 NEW STANDARD 842 P ET
M&M MS NEW STANDARD 3517 PLDET
M&M MS STEALTH 9509 PLD
• Powerhouse son of DC/CRJ Tank E108 P and the proven donor dam M&M New Standard 3517 PLDET
• One of a kind sire with a breed leading data set wrapped up in a powerfully-muscled, high-volume body design



Reg# MC362944
BD: August 17, 2012
Frame: 6.6
• Yellowstone will move every area of your program in a positive direction Dam - M&M MS NEW STANDARD 3517 PLDET
BW: 86 lbs
WW: 750 lbs
YW: 1462 lbs
Scrotal: 43 cm
80 | CHAROLAIS
ET
80 | CHAROLAIS
REG.#BORNFRAMEBWWWYWSCROTAL
EPD 160.70.50.998 ACC 0.050.060.070.08
60203075
RANK%
| NGC YELLOWSTONE 939G ET | $30
Sire - DC/CRJ TANK E108 P
LEVEL UP
MXS VERMILLION 527R
MERIT ROUNDUP 9508W
0200CH50321 | KS LEVEL UP 13H | $25
MERIT YOLANDA 7244T
HC YACHTZEE 166Y
VMN DON’T BLINK 20D
VMN WHAT LUCK PLD 937W
• Homozygous Polled


• Level Up offers moderate BW in a heavily muscled, deep-bodied, and structurally-sound package backed by a highly maternal, productive dam with great udder quality

• Top level actual performance data combines with high genetic predictions for carcass quality
REG.#BORNFRAMEBWWWYWSCROTAL
M955204 2020/01/236.5yrl90lbs972lbs1592lbs39.0cmyrl
MC798949 KS13H--matRatio--Ratio--Ratio----cmmat
Reg# MC798949
BD: January 23, 2020
Frame: 6.5
CCA-W22CEBWWWYWMILK
EPD 5.8-0.54710014
ACC 0.350.580.380.320.27
RANK% 55354020100
CCA-W22CWTMARBREAFAT
EPD 190.610.470.007
ACC 0.150.170.190.24
RANK% 40254015
BW: 91 lbs
Dam - VMN DON’T BLINK 20D
WW: 972 lbs
YW: 1592 lbs
Scrotal: 39 cm
81 | CHAROLAIS 81 | CHAROLAIS
Sire - MERIT ROUNDUP 9508W
RAMPART
LT JOURNEY 5208 PLD
LT RANSOM 8644
LT SHEILA 337 PLD
LT TIOGA 6281
LT SHELIA 8574 P
LT SHEILA 6484 PLD
• Deep-sided and stout-made individual that grabs your attention with his good looks and impeccable structure
• Balanced trait LT Ransom son with noted calving ease credentials selected from the 2022 LT Ranch sale


REG.#BORNFRAMEBWWWYWSCROTAL
M963094 02/15/2021yrl87lbs751lbs1289lbscmyrl
matRatio103Ratio102cmmat
AICA_W22CEBWWWYWMILK
EPD 13.9-35910428
ACC 0.280.400.310.320.13
RANK% 310455020
AICA_W22CWTMARBREAFAT
EPD 160.280.60.012
ACC 0.180.140.180.17
RANK% 7547555
Reg# M963094
BD: December 22, 2019
Frame: 6.6
• Started with an 87 lb birthweight and performed well to index 103 at weaning and 102 at yearling in a large contemporary group SIRE - LT RANSOM 8644

BW: 90 lbs
WW: 751 lbs
YW: 1289 lbs
Scrotal: 43 cm
| LT RAMPART 1713 | $30
0200CH50720
82 | CHAROLAIS MGS - LT LONG DISTANCE 9001 P
GRIFFIN
RBM FARGO Y111
CEDARLEA TAPADERO 17G
CEDARLEA UZA 44Y
WCR COMMISSIONER 593 P
KAYR MISS 753E
KAYR MISS 804U
• Attractive and smooth-made with proven calving ease lineage
• If you’re in search of a heifer bull that won’t sacrifice growth, then Griffin is the sire for you!


• Sound-structured and easy-moving with desirable foot shape
REG.#BORNFRAMEBWWWYWSCROTAL
2021-01-23yrl85lbs780lbs733lbs34.5cmyrl
PMC822858 matcmmat
Reg# PMC822858
BD: January 24, 2021
Frame:
CCA-W22CEBWWWYWMILK
EPD 14-2.9479420
ACC 0.170.370.230.140.09
RANK% 310453560
CCA-W22CWTMARBREAFAT
EPD 170.680.631.201
ACC 0.080.060.080.11
RANK% 55201085
BW: 85 lbs
MGS - WCR COMMISSIONER 593 P
WW: 733 lbs
YW: -
Scrotal: 35 cm
83 | CHAROLAIS 83 | CHAROLAIS
| KAYR GRIFFIN 753J | $25
0200CH50718
BLUEPRINT
RBM TR RHINESTONE Z38
TR CAG CARBON COPY 7630E ET
0200CH50323 | DCR BLUEPRINT J7 | $30
M&M MS CARBINE 1567 PLD
DC/CRJ TANK E108 P DCR MS TANK G317
DCR MS 8141 LADY DUKE A4
• Three dimensional powerhouse! One of the most powerful Carbon Copy sons we’ve come across
• Tremendous depth, thickness and soundness with a pleasing look
• He ranks in the top 1% for MTL; 2% Milk; 3% YW, CW; 6% WW; 5% TSI; 20% CE plus in the top 35% for BW



REG.#BORNFRAMEBWWWYWSCROTAL
M959738 2021-01-306.3yrl89lbs807lbs1455lbs38.5cmyrl matRatio99.0Ratio102.0Ratio109.0cmmat
• Out of a very good uddered first calf heifer sired by a DC/CRJ Tank E108
Reg# M959738
BD: January 30, 2021
Frame: 6.3
AICA_W22CEBWWWYWMILK
EPD 10.2-17213336
ACC 0.300.400.310.320.15
RANK% 2035632
AICA_W22CWTMARBREAFAT
EPD 390.090.750
ACC 0.170.130.170.16
RANK% 3604030
BW: 89 lbs
Sire - TR CAG CARBOBN COPY 7630 ET
WW: 807 lbs
YW: 1455 lbs
Scrotal: 39 cm
84 | CHAROLAIS 84 | CHAROLAIS
MGS
DC/CRJ TANK E108 P
-
BACKWATER JACK
SCC O’RAILLE 181C PLD PVF RIDGE 7142
PVF CHISUM 1340
M&M OUTSIDER 4003 PLD BRCHE TR DORY 6501
TR MS KATIE 4724B ET
• Fresh outcross genetics by PVF Ridge, backed by the no-miss, high quality donor dam, Brche TR Dory
• Impeccable high quality phenotype with all the fundamentals to be a difference making sire
• Lead off bull in WIA’s Champion Pen of Bulls at the 2021 Cattlemans Congress, and National Charolais Sale topper, who then went on to be crowned the 2021 National Champion Bull



Reg# PMC807399
BD: April 4, 2020
Frame:BW: 72 lbs
Dam - BRCHE TR DORY 6501
WW: 841 lbs
YW: -
Scrotal: -
85 | CHAROLAIS
85 | CHAROLAIS REG.#BORNFRAMEBWWWYWSCROTAL
CCA-W22CEBWWWYWMILK EPD 7.4-0.7519521 ACC 0.140.250.160.140.05
CCA-W22CWTMARBREAFAT EPD 211.070.541.353 ACC 0.070.050.070.08
30102590
Owned by Serhienko Char, Hunter Char, Semex & Footprint Farms
EM943105 2020/04/04yrl72lbs841lbscmyrl PMC807399 matRatio93.0Ratio102.0cmmat
RANK% 3530253060
RANK%
WIA BACKWATER
P
316CH0038 |
JACK 060
| $65
Sire - PVF RIDGE
7142
Owned by Derry & Mary Wright, Wild Indian Acres, Tom & Jen Cannon
VAN HALEN
HEJ CHESTER 1C
HEJ EINSTEIN 28E
0200CH50322 | TRI-N VAN HALEN 48H | $25
HEJ CATALINA SUNRISE 68C
TWN YANGSTER 27Y
TRI-N DAISY 627D
TRI-N DAISY 326A
• Homozygous polled
• Curve bending outcross sire providing unlimited mating flexibility


• Stout-made with an attractive look with large scrotal and excellent haircoat
REG.#BORNFRAMEBWWWYWSCROTAL
M958157 2020-02-19yrl90lbs819lbs1481lbs39.0cmyrl
PMC798048 NMF48HmatRatio103.0Ratio93.0Ratio103.0cmmat
Reg# PMC798048
BD: February 19, 2020
Frame: -
CCA-W22CEBWWWYWMILK
EPD 8.9-0.25010115
ACC 0.330.630.410.360.23
RANK% 2535302095
CCA-W22CWTMARBREAFAT
EPD 190.870.530.515
ACC 0.170.170.190.25
RANK% 40152540
BW: 90 lbs
Sibling to Dam of Van Halen
WW: 819 lbs
YW: 1481 lbs
Scrotal: 39 cm
86 | CHAROLAIS 86 | CHAROLAIS
Owned with Serhienko Char, Hunter Char, Semex & Footprint Farms
CASINO
PFMC7880 UNO SC
PFMC8960 EXOTIC SC
7121434650 VARSOVIE
FMC8152 MBZF CHIEF 14S
FFC14301 WR ULTRA 136U
FFC11815 WR HOPE 4H
• Polled
• Unique full French pedigree that can provide Charolais breeders a new pedigree with a very smooth, complete look



• Will add muscle shape and thickness while maintaining an attractive shoulder and bone structure
REG.#BORNFRAMEBWWWYWSCROTAL
FFM911402 2015-08-126.4yrl95lbs639lbs1045lbs40cmyrl
MC711328 FDE375C--matRatio99Ratio--Ratio----cmmat
Reg# MC711328
BD: August 12, 2015
Frame: 6.4
Owned by Serhienko Char, Hunter Char, Semex & Footprint Farms
CCA-W22CEBWWWYWMILK
0.43.3448514 ACC 0.330.640.380.290.21
RANK% 9590555595
RANK% 5510012
BW: 95 lbs
Sire - PFMC8960 EXOTIC SC
WW: 639 lbs
YW: 1045 lbs
Scrotal: 40 cm
CASINO 2018
EPD
EPD
ACC
CCA-W22CWTMARBREAFAT
17-0.620.88-0.73
0.150.160.180.24
| DALMAS CASINO 375C | $25
0200CH50315
87 | CHAROLAIS 87 | CHAROLAIS
HEREFORD

BOLDER
TH 121L 63N TUNDRA 16S
TH 22R 16S LAMBEAU 17Y
0200HP40317 | CSC 701 BOLDER 901 | $30
TH 62N 3L KELSEY 22R
CHURCHILL SENSATION 028X
CSC 502 LADY DEW 701
CSC 10Y LADY DEW 502ET
• Homozygous Polled
• Bold-ribbed, big-hipped and stout-made calving ease specialist whose first progeny have been receiving rave reviews
• 5-year-old dam, granddam and third dam are exceptional females stemming from the same cow family as breed legend NJW 88X



• Top of the breed rankings for CE, BW, teat, and udder
REG.#BORNFRAMEBWWWYWSCROTAL
P44030061 2019/02/205.7yrl79lbs749lbs1191lbs39.0cmyrl
C03069531 901--matRatio--Ratio--Ratio----cmmat
Reg# C03069531
BD: February 20, 2019
Frame: 5.7
CHA-W22CEBWWWYWSC
EPD 13.9-3.350.482.71.2
ACC 0.430.740.560.540.42
RANK% 22696422
CHA-W22MARBREAFAT$CHB
EPD 0.120.240.098110
ACC 0.100.100.10
RANK% 3983100
Owned with CSC Herefords
CHA-W22MILKTMMCESCFCOWWUDDERTEAT
EPD 34.359.54.224.576.61.41.5
ACC 0.31-0.310.340.370.460.47
RANK% 82323182
BW: 79 lbs
WW: 749 lbs
YW: 1191 lbs
Scrotal: 39 cm
MGD - CSC 10Y LADY DEW 502ET 89 | HEREFORD
Dam - CSC 502 LADY DEW 701
BIG COUNTRY
TH 403A 475Z PIONEER 358C ET
TH FRONTIER 174E
0200HP40318 | TH BIG COUNTRY 537G ET | $35
FTF TRUSTING LADY 312A
FTF PROSPECTOR 145Y
TH 506X 145Y DOMINETTE 533B ET
TH 122 71I DOMINETTE 506X ET
• One of the most highly regarded sires ever produced in the Topp Herefords program



• Massive in his build and makeup with a striking attractive look
• Pedigree steeped in calving ease and maternal traits
REG.#BORNFRAMEBWWWYWSCROTAL
P44004759 2019/02/076.2yrl85lbs820lbs1230lbs37.0cmyrl
C03071656 537G--matRatio--Ratio--Ratio----cmmat
Reg# C03071656
BD: February 7, 2019
Frame: 6.2
CHA-W22CEBWWWYWSC
EPD 11.4-2.263.899.91.2
ACC 0.470.780.580.580.53
RANK% 42131822
CHA-W22MARBREAFAT$CHB
EPD 0.060.620.108121
ACC 0.280.240.34
RANK% 6111100
Owned with Topp Herefords
CHA-W22MILKTMMCESCFCOWWUDDERTEAT
EPD 45.477.34.518.250.21.31.4
ACC 0.30-0.300.320.340.470.50
RANK% 11202100
BW: 85 lbs
Progeny at Topp Herefords
WW: 820 lbs
YW: 1230 lbs
Scrotal: 37 cm
Progeny at Topp Herefords
90 | HEREFORD
90 | HEREFORD
EXPLORER
HUTH PROSPECTOR K085
FTF PROSPECTOR 145Y
0200HP40809 | TH 529B 145Y EXPLORER 44D | $25
FTF CHICK A BOOM 7227T
TH 22R 16S LAMBEAU 17Y
TH 60W 11X MS DOM 529B ET
TH 77S 45P RUBY 60W
• Homozygous Polled
• Selected from the 2017 Topp Hereford bull sale as the featured CE option


• Exceptional pigment in a moderate, easy-fleshing package
REG.#BORNFRAMEBWWWYWSCROTAL
43694377 2016/01/125.7yrl71lbs788lbs1232lbs36.2cmyrl
C03038429 44D6matRatio--Ratio--Ratio----cmmat
Reg# C03038429
BD: January 1, 2016
Frame: 5.7
CHA-W22CEBWWWYWSC
EPD 6.5-1.148.478.91.1
ACC 0.500.730.600.580.48
RANK% 193767431
CHA-W22MARBREAFAT$CHB
EPD 0.390.250.058138
ACC 0.240.220.30
RANK% 48192
Owned with Topp Herefords and BNC Polled Herefords

CHA-W22MILKTMMCESCFCOWWUDDERTEAT
EPD 23.747.95.414.756.81.41.4
ACC 0.33-0.380.330.340.530.54
RANK% 6573132599
BW: 71 lbs
Progeny of Explorer
WW: 788 lbs
YW: 1232 lbs
Scrotal: 36 cm
Progeny of Explorer
91 | HEREFORD
91 | HEREFORD
BUCCANEER
CHURCHILL RED BULL 200Z FRENZEN BAR JZ BRUISER B30
0200HP40712 | BAR JZ BUCCANEER 210E | $25
FRENZEN LADY S38
LCG MASTER ONE WAY 51U BAR JZ FERN 531Y
BAR JZ CLASS ACT 538T
• Homozygous Polled
• His smooth angular shoulder coupled with ranking atop the breed for CE and low BW make Buccaneer an ideal candidate for breeding heifers


• Very sound and fluid in his movements
• Outcross pedigree on his maternal side
REG.#BORNFRAMEBWWWYWSCROTAL
43797256 2017/03/116.0yrl82lbs706lbs1245lbs37.0cmyrl
C03045178 210E--matRatio--Ratio--Ratio--cmmat
Reg# C03045178
BD: March 11, 2017
Frame: 6.0
CHA-W22CEBWWWYWSC
EPD 14.7-1.256.578.11.9
ACC 0.500.760.660.660.55
RANK% 1340761
CHA-W22MARBREAFAT$CHB
EPD 0.040.690.048120
ACC 0.250.220.30
RANK% 68687
CHA-W22MILKTMMCESCFCOWWUDDERTEAT
EPD 33.561.89.520.559.31.51.7
ACC 0.33-0.350.280.370.530.53
RANK% 10161198
BW: 82 lbs
Sire - FRENZEN BAR JZ BRUISER B30

WW: 706 lbs
YW: 1245 lbs
Scrotal: 37 cm
92 | HEREFORD 92 | HEREFORD
Dam - BAR JZ FERN 531Y
Owned with Bar JZ Polled Herefords
ULTIMATE
KJ 426T VINCENT 993W
VCR 993W ULTIMATE 236Z
0200HP40806 | JDH 4X ULTIMATE 236Z 94B | $25
VCR 310N MISS DESIRE 609S
KJ 2403 RECRUIT 966R
JDH AH VIOLETS RECRUIT 4X ET
CRR D03 VIOLET 349
• Homozygous Polled

• Was a standout in Delaney’s champion carload pen of bulls


• Sired the Sr Heifer Calf Champion as well as Champion Get of Sire 2019 Toronto Royal
• Stems from one of Delaney Herefords top cow families
REG.#BORNFRAMEBWWWYWSCROTAL
43468994 2014/03/026.3yrl83lbs651lbs1321lbs40.0cmyrl
C03005699 94B--matRatio--Ratio--Ratio----cmmat
Reg# C03005699
BD: March 2, 2014
Frame: 6.3
CHA-W22CEBWWWYWSC
EPD 0.85.157.186.21.5
ACC 0.490.790.650.630.38
RANK% 679137536
CHA-W22MARBREAFAT$CHB
EPD -0.110.410.02898
ACC 0.200.180.24
RANK% 984863
CHA-W22MILKTMMCESCFCOWWUDDERTEAT
EPD 23.752.3410.686.11.41.4
ACC 0.37-0.420.300.350.570.57
RANK% 6555257462
BW: 83 lbs
MGD - CRR D03 VIOLET 349
WW: 651 lbs
YW: 1321 lbs
Scrotal: 40 cm
Progeny of Ultimate
93 | HEREFORD
93 | HEREFORD
RIB EYE
KCF BENNETT 3008 M326
SHF RIB EYE M326 R117
0200HP40313 | BURNSIDE RIB EYE 13Z | $30
HVH MISS HUDSON 83K 8M
GLENLEES CL 151L RIGID 23P
BURNSIDE YEDDA 9W
OLTN 125J YEDDA 43R
• Very easy-fleshing and soft in his makeup
• EU Qualified bull
• Highly proven pedigree with breed legends


Ribeye and Rigid at the forefront
• Moderate design coupled with an abundance of thickness and muscle expression
REG.#BORNFRAMEBWWWYWSCROTAL
43738089 2012/01/305.5yrl81lbs722lbs37.0cmyrl
C02969704 HAND13Z5.5matRatio--Ratio--Ratio--42.0cmmat
Reg# C03005699
BD: January 30, 2012
Frame: 5.5
CHA-W22CEBWWWYWSC
EPD 9.40.448.666.90.5
ACC 0.440.630.520.510.38
RANK% 79769390
CHA-W22MARBREAFAT$CHB
EPD 0.10.61-0.032
ACC 0.240.240.28
RANK% 46121
CHA-W22MILKTMMCESCFCOWWUDDERTEAT
EPD 18.542.80.616.468.41.11.1
ACC 0.29-0.320.340.350.430.44
RANK% 8888652192
BW: 81 lbs
Dam Udder

WW: 722 lbs
YW:
Scrotal: 37 cm
MGS - GLENLEES CL 151L RIGID 23P
94 | HEREFORD
SHORTHORN

PHANTOM
BONNYVIEW HERO 7Z
MURIDALE IRON MAN 4X
0200SP00302 | MURIDALE PHANTOM 10F | $25
MURIDALE MOLINARI 8P
SASKVALLEY BONANZA 219M
MURIDALE GOOSE 76Y
MURIDALE SWAN 54N
• Polled 100% Shorthorn


• Top level calving ease, marbling and stayability from a pedigree highly regarded for maternal function
• Deep-sided, easy-fleshing sire with excellent foot shape and desirable skull structure

REG.#BORNFRAMEBWWWYWSCROTAL
x4306091 2018/03/20--yrl90lbs714lbs1106lbs--cmyrl
M481278 BSX10F--matRatio--Ratio--Ratio----cmmat
• Selected to follow up the globally successful Semex sire Saskvalley Yesterday
Reg# M481278
BD: March 20, 2018
Frame: -
ASA-W22CEDBWWWYWMK
EPD 81.40477326
ACC 0.480.600.510.490.15
RANK% 5040353520
BW: 90 lbs
Dam - MURIDALE GOOSE 76Y
WW: 714 lbs
YW: 1106 lbs
Scrotal:Progeny
96 | HEREFORD 96 | HEREFORD
96 | SHORTHORN
FLASH
SASKVALLEY TRADITION 106T STUDER’S UNIVERSAL 10B
ASA-W22CEDBWWWYWMK
EPD 103.306911427
ACC 0.540.710.660.630.16
RANK% 35752115
179SP00250 | BYLAND FLASH 9U106 | $75
DSF PRIMROSE 55S
JSF MCCOY 39Z
BYLAND CINDY BEAUTY 5M106
BYLAND CINDY BEAUTY 2RW97
• 98.3% pure, Homozygous Polled
• Quickly making a name for himself creating eye appealing, sought after progeny with strong performance attributes
• Strong maternal pedigree hailing from the great Cindy Beauty cow family



• Ranks in the top 15% of the breed for CE, while ranking in the top 5% or better for performance traits
Owned by Byland
Reg# x4294954
BD: April 8, 2019
Frame: 5.6
Progeny of Flash
BW: 70 lbs
WW: 684 lbs
YW: 1273 lbs
Scrotal: 40 cm
Progeny of Flash
REG.#BORNFRAMEBWWWYWSCROTAL x4294954
2019/04/085.6yrl70lbs684lbs1273lbs39.5cmyrl 9106matRatio116.0Ratio107.0Ratio109.0cmmat
97 | SHORTHORN
BIG TICKET
SASKVALLEY BONANZA 219M
JDMC BIG SKY 15X
0200SP70801 | JSF BIG TICKET 131D | $25
S ROCKSIE’S MARQUIS 3590
WAUKARU GOLD ELEMENT 156
KL GOLD ROSE
KL DOUBLE ROSE
• An exciting roan bull who is a heifer safe option for shorthorn breeders



• He combines breed leading Calving ease with toptier performance in a unique pedigree package
REG.#BORNFRAMEBWWWYWSCROTAL
x4242283 2016/03/126.3yrl74lbs712lbs1165lbs38.0cmyrl
M480507 131D--matRatio--Ratio--Ratio----cmmat
• A direct son of the famous KL Gold Rose female who is one of the most prepotent females in the history of the breed
Reg# M480507
BD: March 12, 2016
Frame: 6.3
ASA-W22CEDBWWWYWMK
EPD 14-1.5446531
ACC 0.470.550.480.480.22
RANK% 101050604
BW: 74 lbs
WW: 712 lbs
YW: 1165 lbs
Scrotal: 38 cm
Maternal Brother
Dam - KL GOLD ROSE
98 | HEREFORD 98 | HEREFORD 98 | SHORTHORN
Owned with Jungles Shorthorn Farm & Roger Haley Family
LIMOUSIN

GRASS ROOTS
WULFS ZIPLOCK N922Z
LFLC BANK ACCOUNT 701B
LFLC 701X XTRA GOOD
0200LM60313 | BLCC GRASS ROOTS 70G | $30
GREENWOOD CANADIAN IMPACT ET GREENWOOD EVELYN PYN 70E GREENWOOD PLD BOMB SHELL
• The perfect blend of herd improving data with industry leading phenotype
• Dam and granddam are exceptional females with strong maternal traits from the famed Greenwood Limousin program



REG.#BORNFRAMEBWWWYWSCROTAL
CPM4098289 2019/03/02--yrl78lbs827lbs1368lbs35.0cmyrl
CPM4098289 BLC70G--matRatio99.0Ratio102.0Ratio--cmmat
Reg# CPM4098289
BD: February 3, 2019
Frame: -
CLA-W22GESTCEDBWWWYWSCDOC
EPD -515-0.362890.2517
ACC 0.330.500.560.490.480.150.46
RANK% 10101555508010
CLA-W22CWMARBREAFATYG
EPD 32-0.381.22-0.58
ACC 0.430.340.380.32
RANK% 259035
CLA-W22MILKCEMSTAY
EPD 25810 ACC 0.200.250.31
RANK% 301575
BW: 78 lbs
WW: 827 lbs
YW: 1368 lbs
Scrotal: 35 cm
100 | LIMOUSIN
Progeny of Grass Roots
MGD - GREENWOOD PLD BOMB SHELL
100 | LIMOUSIN
CAMDEN YARDS
0200LM60807 | TMCK CAMDEN YARDS 195C | $20
PIONEER 7301
TMCK ALFALFA 35X
TMCK JOYCE 570U
MAGS Y-AXIS
TMCK CASUAL AFFAIR 311A
TMCK CASUAL 28Y
• 49.2% Limousin, 48.5% Angus, Homozygous Polled, Homozygous Black



• Tremendous phenotype LimFlex sire being deep-bodied, great-hipped and expressive in his lower quarter with an attractive appealing profile
• Ranks in the top 4% of the breed or better for WW, YW, CEM, CW and MARB
REG.#BORNFRAMEBWWWYWSCROTAL
LFM2077823 2015/02/076.2yrl75lbs952lbs1567lbs34.0cmyrl
LFM2077823 TMCK195C--matRatio96Ratio110Ratio113--cmmat
Reg# LFM2077823
BD: February 7, 2015
Frame: 6.2
CLA-W22GESTCEDBWWWYWSCDOC
EPD -4120.186138112
ACC 0.730.620.770.710.710.580.64
RANK% 252020321550
CLA-W22CWMARBREAFATYG
EPD 430.180.99-0.22
ACC 0.520.450.460.37
RANK% 10375
CLA-W22MILKCEMSTAY
EPD 351012
ACC 0.500.440.36
RANK% 2560
BW: 75 lbs
Full Sister to Dam
WW: 952 lbs
YW: 1567 lbs
Scrotal: 34 cm
Progeny of Camden Yards
S A V
101 | LIMOUSIN
101 | LIMOUSIN
FORMATION
SYDGEN C C & 7
HOOVER DAM
ERICA OF ELLSTON C124
0200LM60312 | WULFS FORMATION 5628F | $30
WULFS ZAMBONI N903Z WULFS CUPIDS ARROW 5628C
JBAK PAGODA 696P
• Homozygous polled, Homozygous Black


• Outstanding phenotype Wulf LimFlex sire being smooth-made, yet stout and muscular

• Top ranking calving ease with solid performance and exceptional Marbling
• Top 4% Calving Ease with top 5% YW and 1% marbling
REG.#BORNFRAMEBWWWYWSCROTAL
LFM2151633 2018/08/26--yrl85lbs613lbs1244lbs36.5cmyrl
LFM2151633 FI5628F--matRatio101Ratio109Ratio104--cmmat
Reg# LFM2151633
BD: August 26, 2018
Frame: -
CLA-W22GESTCEDBWWWYWSCDOC
EPD -1140.6691131.210
ACC 0.200.450.490.460.470.260.41
RANK% >95420205265
CLA-W22CWMARBREAFATYG
EPD 450.110.94-0.27
ACC 0.430.410.410.35
RANK% 1190
CLA-W22MILKCEMSTAY
EPD 17615
ACC 0.220.270.33
RANK% 953030
BW: 85 lbs
Sire - HOOVER DAM
WW: 613 lbs
YW: 1244 lbs
Scrotal: 37 cm
Sibling to Formation
102 | LIMOUSIN 102 | LIMOUSIN



103 | SPECKLE PARK 103 | LIMOUSIN K C F BENNETT ABSOLUTE WULFS PERSEPHONE 5566C ROYAL PERSEPHONE DRCC 0087X JCL LODESTAR 27L RUNL STETSON 850S RUNL 72L 0200LM60315 | WULFS HALIBUT 5566H | $25 Reg# LFM2275589 | BD: February 16, 2020 | Frame: 6.3 | BW: 92 lbs | WW: 763 lbs | YW: 1290 lbs | Scrotal: 37 cm HALIBUT WULFS YOGI 1020Y WULFS LUCY 5942C ROYAL LUCY DRCC 1007H 0200LM60314 | WULFS HAWTHORNE E006H | $25 Reg# LFM2272874 | BD: January 4, 2020 | Frame: 5.3 | BW: 61 lbs | WW: 790 lbs | YW: 1155 lbs | Scrotal: 33 cm JCL LODESTAR 27L RUNL STETSON 850S RUNL 72L HAWTHORNE RUNL STETSON 850S WULFS ELLESSE 7201E WULFS ZOWNY 2420Z WULFS YOGI 1020Y WULFS DEVLIN K684D ET WULFS SOLOIST 6284S 0200LM60316 | WULFS HANG UP 7201H | $25 Reg# LFM2275699 | BD: February 26, 2020 | Frame: 5.5 | BW: 79 lbs | WW: 717 lbs | YW: 1211 lbs | Scrotal: 36 cm HANG
NALF-W22GESTCEDBWWWYWSCDOC EPD -213-0.0563971.114 ACC 0.280.490.520.510.520.260.47 RANK% 70252080803035 NALF-W22MILKCEMSTAY EPD 18518 ACC 0.260.320.35 RANK% 80752 NALF-W22CWMARBREAFATYG EPD 270.221.09-0.4 ACC 0.490.470.470.39 RANK% 754510 REG.#BORNFRAMEBWWWYWSCROTAL LFM2275699 2020-02-265.5yrl79lbs717lbs1211lbs36.3cmyrl LFM2275699 FI7201HmatRatio92.0Ratio108.0Ratio95.0cmmat CLA-W22GESTCEDBWWWYWSCDOC EPD -216-1.564840.715 ACC 0.250.430.480.450.470.250.43 RANK% 801340652515 CLA-W22MILKCEMSTAY EPD 23712 ACC 0.190.240.31 RANK% 501575 CLA-W22CWMARBREAFATYG EPD 210.091.1-0.44 ACC 0.410.390.390.33 RANK% 50255 REG.#BORNFRAMEBWWWYWSCROTAL LFM2272874 2020-01-045.3yrl61lbs790lbs1155lbs33.4cmyrl LFM2272874 FIE006HmatRatio77.0Ratio98.0Ratio80.0cmmat CLA-W22GESTCEDBWWWYWSCDOC EPD -321-362870.816 ACC 0.290.490.510.500.510.280.44 RANK% 501150551510 CLA-W22MILKCEMSTAY EPD 191218 ACC 0.260.310.33 RANK% 85110 CLA-W22CWMARBREAFATYG EPD 170.160.87-0.31 ACC 0.490.460.470.39 RANK% 65195
UP
JUDGEMENT CALL
0200SK00702 | KFC JUDGEMENT CALL 301J | $45
RIVER HILL 26T WALKER 60W
RIVER HILL 60W EXCALIBUR 345E
PRARIE HILL DREAMER 88K
SPOTS N’ SPROUTS ZENITH 106Z
RIVER HILL COME AWAY W/ME 9C
RIVER HILL 64S WYLDA 09W
• Judgement Call sparked worldwide interest as the much sought after, high selling bull in the 2022 KFC Farms sale



• Powerfully built with softness, soundness and a great eye-appealing look
• Judgement Call is the Speckled Park sire to tie into
Reg# 13787
BD: January 1, 2021
Frame: -
9C
BW: 85 lbs
WW: 788 lbs
YW: 1425 lbs
Scrotal: -
60W EXCALIBUR 345E
Dam - RIVER HILL COME AWAY W/ME
Sire - RIVER HILL
104 | LIMOUSIN 104 | SPECKLE PARK
TRADE SECRET
0200SK00701 | JSF TRADE SECRET 11A | $25
REDNECK WILD WILLY 2W (AI( (P)
YOGI GOES REDNECK 7Y
ASPEN ACRES LINDA LOU 10L
RIVER HILL SHOW BIZ 93S (P)

MONNERY RIVER 7W (P)
MONNERY RIVER 7P
Reg# 4414-PT | BD: March 9, 2013 | Frame: | BW: 77 lbs | WW: 810 lbs | YW: 1380 lbs | Scrotal: 36 cm
MATTERS
0200SK00300 | DANGIT MATTERS 22D | $25
CLEAR VIEW TY 205R
CODIAK LANE GNK 56A
CODIAK NAMELESS RKW 45N
Reg# 6284-PB | BD: March 14, 2013 | Frame: 5.0 | BW: 77 lbs | WW: | YW: | Scrotal:
UNEEDA YOUNGBLOOD 105Y THE JEWELS MATTERS 1A
SPOTS ‘N SPROUTS JULIET 2Y
EXTREME
0200SK00301 | ANDCHRIS EXTREME 23E | $25
RAVEN MEADOWS MAGNUM 10N UPTO SPECS ULYSSES 25U
PRAIRIE HILL REBA 154F

Reg# 8242-PB | BD: February 24, 2017 | Frame: | BW: 95 lbs | WW: 850 lbs | YW: 1430 lbs | Scrotal:

SPOTS ‘N SPROUTS UNO 102U SECOND CHANCE ZOEY 3Z
TIA-ROSE OF SARA LEE 3T
105 | SPECKLE PARK
SUPREMACY
BLACKWATER AINSLEY HALLFIELD ICARUS
0200BD00301 | SMX SUPREMACY 1750 | $25
HALLFIELD SARAH
TOP NATURS TOPPER 011C
HIGH ROCK CRISP 5U
YOUNG CREST FRITZ 21F
• Impressive, well-muscled sire with sound structure and depth of body


• Son of the popular UK sire Hallfield Icarus who is known for his calving ease, performance and muscling

• Polled
Reg# [CAN]D16333-T
BD: September 23, 2017
Frame: -
BW: 106 lbs
WW: -
YW: -
Scrotal: -
Dam - HIGH ROCK CRISP 5U
106 | LIMOUSIN 106 | BLONDE
Mat Sister to Dam
0200BB00908 | LITTLEBANK MARIO | $25
Reg# | BD: July 14, 2017 | Frame: | BW: - | WW: - | YW: - | Scrotal: -
MONSTER MUNCH
0200BB00909 | BLACK N BLUE MONSTER MUNCH | $25
TENACE DE LA PRAULE
AGILE DE LA PRAULE
QUESTURE LA PRAULE
HEROS DU PEROY
LITTLEBANK GEORGEOUS
LITTLEBANK DIVA
BIONIQUE DU PRE ROSINE JIOSCO DE FOCANT
QUATORZE DE FOCANT
Reg# | BD: September 8, 2017 | Frame: - | BW: - | WW: - | YW: - | Scrotal: -
LABEL DE SPY BLACK N BLUE EMPRESS BLACK N BLUE UK.COM
IMPERIAL DE L’ECLUSE PIVERT DES ALLEINES



HUITIEME DES ALLEINES
0200BB00911 | REDMIRES ORION | $25
Reg# | BD: January 26, 2019 | Frame: - | BW: - | WW: - | YW: - | Scrotal: -
TWEEDDALE GEE WHIZ REDMIRES LIBRA
PENDLE GEMINI
MARIO
ORION
107 | BRITISH BLUE
RESILIENT
LAZY TV SAM U451
CAROLINA LEVERAGE 3214A
0200GV00704 | DDGR RESILIENT 275D | $25
BELLE OF THE BALL 1309Y
POST ROCK SILVER 233U1
DDGR 129Z
MANDY 32S
• Polled Black Purebred
• Backed by the most influential cow family at Gustins
• Maternal brother, American Sniper, was high seller in the 2015 Diamond D Bull Sale



REG.#BORNFRAMEBWWWYWSCROTAL
AMGV1355159 2016/03/056.4yrl94lbs731lbs1351lbs41.5cmyrl
275D--matRatio--Ratio103Ratio103--cmmat
Reg# CDGV145131
BD: March 5, 2016
Frame: 6.4
CGA-W22BWWWYWMILK
EPD 3.39213923
ACC 0.780.760.740.76
RANK% 902335
BW: 94 lbs
WW: 731 lbs
YW: 1351 lbs
Scrotal: 41.5 cm
Maternal Brother
108 | GELBVIEH
Progeny
Owned by Diamond D Gelbvieh, Royal Western Gelbvieh, Rocky Top Gelbvieh
KUNE
0200KB00309 | LLN KUNE 1029G ET | $30
JVP FUKUTSURU-068
BAR R JIRO 22T
BAR R MISS 2N
Reg# FB46604 | BD: June 26, 2019 | Tenderness: 10 | Quality Grade: AWA | BW: 66 lbs



WSI OKUKANEMICHI
KUN KUNTZIDE E8 ET
KUNTZIDE MS AMAZING
SANJIRO 3
SANJIRO 5U
KOBE MIZUTANI 607E
0200KB00308 | SMX SANMARRO 1836F | $30
Reg# FB37157 | BD: July 9, 2018 | Tenderness: 6 | Quality Grade: AWA | BW: 77 lbs | WW: 624 lbs
MAZDA WAGYU JAMES SMX NAGATAKU
MAZDA WAGYU MAZATLAN
TWA KOTSUKARI
MAZDA WAGYU KOTSAWA Z0004
ASHWOOD V4
0200KB00307 | SMX KOMAKI 1842F | $25
Reg# FB42729 | BD: September 11, 2018 | Tenderness: | Quality: | WW: 606 lbs
ASHWOOD F X007
SMX NADAKU
KALANGA EMPRESS NAMI D053
109 | ANGUS 109 | WAGYU
KOMAKI
SANMARRO
COAT COLOR INHERITANCE IN BEEF CATTLE
There are a number of sets of genes that determine coat color in cattle.

THE MOST COMMON SETS ARE:
• Basic coat color
• Dilution of basic color
• Inhibitor (eg. Charolais .. absence of color)
• Solid Pattern
• White Face
• Spotted
THERE ARE THREE FORMS OF THE GENE THAT CONTROL THE Color:
Rb Black Gene
R Red Gene
r White Gene
Every Animal carries two genes for basic coat color. An animal homozygous for that gene will breed true and can only pass that type onto his progeny such as RbRb Homozygous for Black.
THERE ARE SIX POSSIBLE COMBINATIONS OF BASIC COAT Color:
RbRb Animal is Black (or Gray) Homozygous Black
RbR Animal is Black (or Gray) Heterozygous Black, Heterozygous Red
RR Animal is Red Homozygous Red
Rr Animal is White Homozygous White
Rbr Animal is Black or Gray Roan Heterozygous Black, Heterozygous White
Rr Animal is Red Roan Heterozygous Red, Heterozygous White
DILUTION GENE:
D Dilution Gene – Dominates causing coat color to be diluted
d Non Dilution Gene – Recessive form of gene. Does not dilute coat color
EACH ANIMAL CARRIES TWO COPIES OF THE DILUTION GENE:
DD Homozygous for dilution and the animal will be Diluted in color. Dilutes Black to Gray and Dilutes Dark Red to light red or yellow
dd Recessive and Homozygous non-dilution. The animal will not be diluted. Does not dilute black or red color
Dd Heterozygous for dilution. The animal will be diluted in color.
110
TERMINOLOGY & DEFINITIONS
PERFORMANCE DATA
BWT (Birth Weight)
WWT (Weaning Weight)
YWT (Yearling Weight)
SC (Scrotal Circumference)
PUREBRED Purebred is defined as having the blood percentage of the breed at 99.9 % or less and have some influence of blood from another breed.
FULLBLOOD Fullblood cattle are 100% pure and have no influence from any other breed.
FLECKVIEH Fleckvieh is the German or Austrian term for Simmental. This term is used to describe fullblood cattle that are represented in the Semex program with a high percentage of the pedigree derived from original German or Austrian pedigrees.
FRAME SCORE A score based on a subjective evaluation of height or actual measurement of hip height.
SCROTAL CIRCUMFERENCE Actual scrotal measurment is recorded as close to 12-14 months of age as possible.
HETEROZYGOUS POLLED These bulls are polled but carry one polled gene and one horned gene, therefore, they may sire horned calves when mated to horned cows or other heterozygous polled cows.
HOMOZYGOUS POLLED These bulls have a 99.9% probability of being homozygous polled, having been verified either through DNA testing or having been verified through mating to horned cows. All calves from these sires will be polled.
POLLED Naturally hornless cattle. Having no horns or scurs.
HORNED These bulls carry the horned gene and will only produce horned calves when mated to other horned females.
HETEROZYGOUS BLACK These sires are black but carry one red gene therefore will produce some red calves when mated to red females.
HOMOZYGOUS BLACK These bulls have a 99.9% probability of being homozygous black. You should expect these bulls to sire black calves when mated to red or black cows. These bulls have been verified through independent third party DNA testing.
DILUTION GENES Cattle carrying dilution or spotter genes will be gray, red or yellow.
NON-DILUTOR These cattle do not carry the dilution gene. The dilution gene causes black coat color to be gray and red coat color to be yellow.
EXPECTED PROGENY DIFFERENCE (EPD) is the prediction of how future progeny of each animal are expected to perform relative to the progeny of other animals listed in the database. EPDs are expressed in units of measure for the trait, plus or minus.
EPDS are enhanced by genomic results generated by:
ACCURACY
ACCURACY (ACC) , is the reliability that can be placed on the EPD. An accuracy of close to 1.0 indicates higher reliability. Accuracy is impacted by the number of progeny and ancestral records included in the analysis.
111
PRODUCTION
CALVING EASE DIRECT (CED) , is expressed as a difference in percentage of unassisted births, with a higher value indicating greater calving ease in first-calf heifers. It predicts the average difference in ease with which a sire’s calves will be born when he is bred to first-calf heifers
BIRTH WEIGHT EPD (BW) , expressed in pounds, is a predictor of a sire’s ability to transmit birth weight to his progeny compared to that of other sires.
WEANING WEIGHT EPD (WW) , expressed in pounds, is a predictor of a sire’s ability to transmit weaning growth to his progeny compared to that of other sires.
YEARLING WEIGHT EPD (YW) , expressed in pounds, is a predictor of a sire’s ability to transmit yearling growth to his progeny compared to that of other sires.
RESIDUAL AVERAGE DAILY GAIN (RADG) , expressed in pounds per day, is a predictor of a sire’s genetic ability for post-weaning gain in future progeny compared to that of other sires, given a constant amount of feed consumed.
YEARLING HEIGHT EPD (YH) , is a predictor of a sire’s ability to transmit yearling height, expressed in inches, compared to the that of other sires.
SCROTAL CIRCUMFERENCE EPD (SC) , expressed in centimeters, is a predictor of the difference in transmitting ability for scrotal size compared to that of other sires.
DOCILITY (DOC) , is expressed as a difference in yearling cattle temperament, with a higher value indicating more favourable docility. It predicts the average difference of progeny from a sire in comparison with another sire’s calves. In herds where temperament problems are not an issue, this expected difference would not be realized.
MATERNAL
HEIFER PREGNANCY (HP) , is a selection tool to increase the probability or chance of a sire’s daughters becoming pregnant as first-calf heifers during a normal breeding season. A higher EPD is the more favorable direction and the EPD is reported in percentage units.
CALVING EASE MATERNAL (CEM) , is expressed as a difference in percentage of unassisted births with a higher value indicating greater calving ease in first-calf daughters. It predicts the average ease with which a sire’s daughters will calve as first-calf heifers when compared to daughters of other sires.
MATERNAL MILK EPD (MILK) , is a predictor of a sire’s genetic merit for milk and mothering ability as expressed in his daughters compared to daughters of other sires. In other words, it is that part of a calf’s weaning weight attributed to milk and mothering ability.
M&G, MWWT OR TM (TOTAL MATERNAL) reflects a sire’s ability to transmit growth genetics combined with milking abilities to his daughters.
MATURE WEIGHT EPD (MW) , expressed in pounds, is a predictor of the difference in mature weight of daughters of a sire compared to the daughters of other sires.
MATURE HEIGHT EPD (MH) , expressed in inches, is a predictor of the difference in mature height of a sire’s daughters compared to daughters of other sires.
STAYABILITY (STAY) is a predictor of the sire’s ability to produce females that produce and have longevity.

COW ENERGY VALUE ($EN) , expressed in dollars savings per cow per year, assesses differences in cow energy requirements as an expected dollar savings difference in daughters of sires. A larger value is more favourable when comparing two animals (more dollars saved on feed energy expenses). Components for computing the cow $EN savings difference include lactation energy requirements and energy costs associated with differences in mature cow size.
CARCASS
CARCASS WEIGHT EPD (CW) , expressed in pounds is a predictor of the differences in hot carcass weight of a sire’s progeny compared to progeny of other sires.
MARBLING EPD (MARB) , expressed as a fraction of the difference in USDA marbling score of a sire’s progeny compared to progeny of other sires.
112
RIBEYE AREA EPD (RE) , expressed in square inches, is a predictor of the difference in ribeye area of a sire’s progeny compared to progeny of other sires.
FAT THICKNESS EPD (FAT) , expressed in inches, is a predictor of the differences in external fat thickness at the 12th rib (as measured between the 12th and 13th ribs) of a sire’s progeny compared to progeny of other sires.
$VALUE INDEXES
$Value indexes are multi-trait selection indexes, expressed in dollars per head, to assist beef producers by adding simplicity to genetic selection decisions. The $Value is an estimate of how future progeny of each sire are expected to perform, on average, compared to progeny of other sires in the database if the sires were randomly mated to cows and if calves were exposed to the same environment.
WEANED CALF VALUE ($W) , an index value expressed in dollars per head, is the expected average difference in future progeny performance for preweaning merit. $W includes both revenue and cost adjustments associated with differences in birth weight, weaning direct growth, maternal milk, and mature cow size.
FEEDLOT VALUE ($F) , an index value expressed in dollars per head, is the expected average difference in future progeny performance for postweaning merit compared to progeny of other sires.
GRID VALUE ($G) , an index value expressed in dollars per head, is the expected average difference in future progeny performance for carcass grid merit compared to progeny of other sires.
QUALITY GRADE ($QG) $QG represents the quality grade segment of the economic advantage found in $G. $QG is intended for the specialized user wanting to place more emphasis on improving quality grade. The carcass marbling (Marb) EPD contributes to $QG.
YIELD GRADE ($YG) $YG represents the yield grade segment of the economic advantage found in $G. $YG is intended for the specialized user wanting to place more emphasis on red meat yield. It provides a multi-trait approach to encompass ribeye, fat thickness and weight into an economic value for red meat yield.
BEEF VALUE ($B) , an index value expressed in dollars per head, is the expected average difference in future progeny performance for postweaning and carcass value compared to progeny of other sires.

SCURS
There are additional genes that affect hornlike growth on an animal’s head. The major gene for scurs, SC, is thought to involve an inheritance process that is separate from the process that determines if an animal is polled. Absence of the scur gene is expressed by the symbol Sn. Scurs are incompletely developed horns which are generally loose and moveable beneath the skin. In older animals they may become attached to the skull. Because the gene for scurs is transmitted separately, it generally has no effect on the presence or absence of horns. Not all cattle carry the gene for scurs and not all polled cattle lack the gene. In a horned herd, the presence of the gene is hidden by the horns and will not be discovered until the horns are bred off.
The way the gene is expressed depends on the sex of the animal. In males, SC is dominant.
This means that the presence of a single SC gene will cause the bull to be scurred. In females, the SC is recessive so a cow must possess two copies of the gene in order to be scurred.
If she possesses one copy of the gene she may pass the scurred condition onto some of her calves but will not be scurred herself.
113
BEEF COW PROTOCOLS - 2022
HEAT DETECTION FIXED-TIME AI (TAI)*
HEAT DETECT & TIME AI (TAI)
Heat detect and AI day 6 to 10 and TAI all non-responders 72 – 84 hr after PG with GnRH at TAI.
Heat detect and AI days 0 to 3. Administer CIDR to non-responders and heat detect and AI days 9 to 12. Protocol may be used in heifers.
Heat detect and AI day 7 to 10 and TAI all non-responders
- 84 hr after PG with GnRH at TAI.
Heat detect & AI days 0 to 3. Administer CIDR to non-responders & heat detect and AI days 9 to 12. TAI non-responders 72 - 84 hr after CIDR removal with GnRH at AI. Protocol may be used in heifers.
FIXED-TIME AI (TAI)*
Select Synch 7 13 PG GnRH 0 6 Heat detect & AI treatment day 7 PG GnRH 0 Heat detect & AI 10 GnRH AI CIDR® Select Synch + CIDR® & TAI
72
.. 72 - 84 hr .. treatment day Select Synch + CIDR® 7 13 0 GnRH PG Heat detect & AI treatment day GnRH 0 6 7 PG Heat detect & AI 10 GnRH AI Select Synch & TAI
.. 72 - 84 hr .. treatment day CIDR® 9 PG Heat detect & AI 12
GnRH 3 0 PG Heat detect & AI
PG 6-day CIDR®
9 PG Heat detect & AI 12 GnRH AI
.. 72 - 84 hr .. GnRH 3 PG
PG 6-day CIDR® & TAI
0 Heat detect & AI CIDR® treatment day treatment day CIDR®
114
BEEF COW SYNCH PROTOCOLS
BEEF COW SYNCH PROTOCOLS
FIXED-TIME AI (TAI)*
7-day CO-Synch + CIDR®
Perform
5-day CO-Synch + CIDR®
Perform
apart are required for this protocol.
FIXED-TIME AI (TAI)* for Bos Indicus cows only
Bos Indicus PG 5-day + CIDR®
Perform TAI at 66 ± 2 hr after CIDR removal with GnRH at TAI.
* The time listed for “Fixed-time AI” should be considered as the approximate average time of insemination. This should be based on the number of cows to inseminate, labor, and facilities.
These protocol sheets were assembled by the Beef Reproduction Task Force; BeefRepro.org. Programs are intended to promote sustainable food production systems by the beef industry through sound reproductive management practices for replacement heifers and postpartum cows. The Beef Reproduction Task Force recommends working with a licensed veterinarian for proper use and application of all reproductive hormones. Approved 12-1-2021.
Cystorelin® , Factrel® , Fertagyl® , OvaCyst® , GONABreed®
® , Estrumate® , In-Synch® ,
GnRH PG estroPLAN
Lutalyse
SYNCHSURE™ PG 9 Heat detect & AI 12 3 0 PG Heat detect & AI 9 PG Heat detect & AI 12 AI .. 72 - 84 hr .. GnRH 3 PG 0 Heat detect & AI CIDR® treatment day treatment day CIDR® CIDR® treatment day 8±2 hr
® , Lutalyse® HighCon, ProstaMate® ,
5 PG 0 8 GnRH AI CIDR® …..66 ± 2 hr.. PG treatment day
TAI
to
7 GnRH 0 10 GnRH AI .. 60 - 66 hr .. treatment day CIDR® 5 PG GnRH 0 8 GnRH AI
at 60
66 hr after PG with GnRH at TAI.
TAI
…..72 ± 2 hr.. Two
PG CIDR® 115
at 72 ± 2 hr after CIDR removal with GnRH at TAI.
injections of PG 8 ± 2 hr
1
BEEF HEIFER SYNCH PROTOCOLS
BEEF HEIFER PROTOCOLS - 2022
HEAT DETECT & TIME AI (TAI)
Heat detect and AI day 7 to 10 and TAI
Heat detect and AI day 33 to 36 and TAI all non-responders
FIXED-TIME AI (TAI)*
Shot PG HEAT
DETECTION
PG Heat detect & AI MGA® -PG & TAI MGA 1 14 PG 33 Heat detect & AI GnRH 36 AI Select Synch + CIDR® & TAI GnRH 0 7 PG Heat detect & AI 10 GnRH AI CIDR®
all non-responders 72 - 84 hr after PG with GnRH at TAI.
72 - 84 hrs after PG with GnRH at TAI. 0 12 5 .. 72 - 84 hr .. .. 72 - 84 hr .. … 19 d … treatment day treatment day ® MGA® -PG MGA 1 14 PG 33 39 Heat detect & AI … 19 d … treatment day 7-day CIDR® -PG 0 7 13 CIDR® PG Heat detect & AI treatment day treatment day 14-day CIDR® -PG & TAI MGA 0 14 PG 30 Heat detect & AI GnRH 33 AI
detect
AI day
all non-responders 72 hrs after PG with GnRH at TAI. … 16 d … treatment day CIDR® ..70 - 74 hr .. Short-term Protocols Long-term Protocols 116
Heat
and
30 to 33 and TAI
7-day
BEEF HEIFER SYNCH PROTOCOLS
FIXED-TIME AI (TAI)*
Short-term Protocols
14-day
Long-term Protocols
5-day CO-Synch + CIDR®
Perform
at 60 ± 4 hr after CIDR removal with GnRH at TAI. Two injections of PG 8 ± 2 hr apart are required for this protocol.
* The times listed for “Fixed-time AI” should be considered as the approximate average time of insemination. This should be based on the number of heifers to inseminate, labor, and facilities.
These protocol sheets were assembled by the Beef Reproduction Task Force; BeefRepro.org. Programs are intended to promote sustainable food production systems by the beef industry through sound reproductive management practices for use in replacement heifers and postpartum cows. The Beef Reproduction Task Force recommends working with a licensed veterinarian for proper use and application of all reproductive hormones. Approved 12-1-2021.
estroPLAN® , Estrumate® , In-Synch® ,
® , SYNCHSURE™
® MGA 1 14 PG 33 39 Heat detect & AI … 19 d … treatment day
CIDR® -PG CIDR ® 0 14 PG 30 33 GnRH AI Perform TAI at 66 ± 2 hr after PG with GnRH at TAI. 66 ± 2 hr treatment day ... 16 d … MGA 0 14 PG 30 Heat detect & AI 33 AI 72 hrs after PG with GnRH at TAI. … 16 d … treatment day CIDR® ..70 - 74 hr .. GnRH 0 7 PG 9 GnRH AI CIDR®
CO-Synch + CIDR® .. 54 ± 2 hr .. treatment day
TAI at 54 ± 2 hr after PG with GnRH at TAI.
Perform
MGA® -PG MGA 1 14 PG 33 36 GnRH AI Perform TAI
… 19 d … 72 ± 2 hr treatment day
at 72 ± 2 hr after PG with GnRH at TAI.
GONABreed
Cystorelin® , Factrel® , Fertagyl® , OvaCyst® ,
®
ProstaMate
GnRH PG
Lutalyse® , Lutalyse® HighCon,
5 PG GnRH 0 7 GnRH AI CIDR® …..60 ± 4 hr.. treatment day PG 8±2 hr
TAI
117
Work donors every 2 weeks and prior to puberty
Industry’s best results for Young Donors x Young Bulls
Industry’s leading conception rates, fresh and frozen

More Embryos Per Donor = More Calves On The Ground




t: 450-774-7949 | www.boviteq.com The Boviteq Difference is at work from coast to coast with huge payoffs growing year after year!
ANGUS
0888AN10337
QUAKER HILL COLUMBUS 6V48
0777AN10384 | 0888AN10384
QUAKER HILL HIGH COTTON 9U17
48 state-of-the-art sorting heads at Semex Headquarters.
Technicians train 300-900 hours depending on the role machines, media and protocols are used to produce a high quality product.
for desired gender purity






every bull sorted. Fertility continues to improve and is tracked on More machines to be installed meet demand! in 2 022 to
Operating 24/7
0777AN10358
CONLEY EXPRESSION 9213
0777AN10329 | 0888AN10329
SPRING GROVE OVERHAUL 6133
CHAROLAIS
0777CH50321 | 0888CH50321








KS LEVEL UP 13H HEREFORD
0888HP10337
BURNSIDE RIB EYE 13Z
LIMOUSIN
0777LM60313 | 0888LM60313
BLCC GRASS ROOTS 70G
46 technicians highly skilled
able with Fertility compar conventional semen
Sexed semen is produced by using the proprietary technology of XY LLC and Inguran LLC.
WAYGU
0777KB00308
SMX SANMARRO 186F

Semen quality is evaluated with cutting-edge technology and equipment 120
October 2021






SLUGGER 0200BR00300 | GKM MR. CLAYTON SLUGGER CLIMAX 0200BN00804 | DMR CLIMAX 30E46 TEXAS STAR DRYTOWN 0200DM00300 | SEMEX DRYTOWN 1841 SANSAO 0200BR00302 | SMX MAJOR SANSAO 5A 0200RR80704 | SMX NORTHERN DALLAS 1936 0200BN00802 | DMR TEXAS STAR 222A47 NORTHERN DALLAS
www.semex.com/beef

 2023 BEEF MANAGEMENT HANDBOOK
2023 BEEF MANAGEMENT HANDBOOK